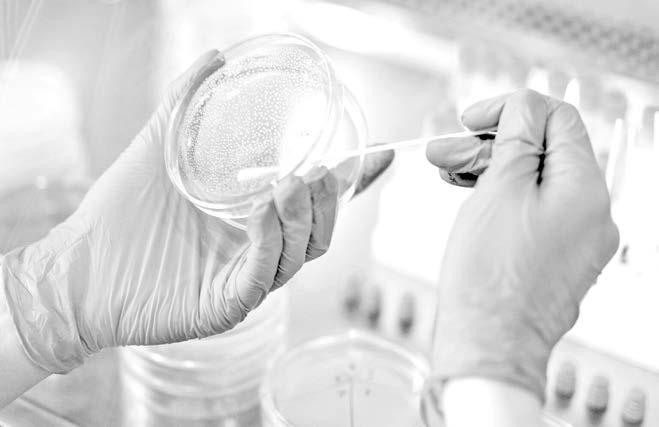

INSTALAN NUEVOS CESTOS DE BASURA
Calles de mayor circulación dispondrán de estos recipientes; piden a población hacer adecuado uso de ellos.

EXPONE SHEINBAUM VISIÓN DE DESARROLLO PARA EL PAÍS
“Hay una enorme oportunidad de generar polos de desarrollo que nos permita atraer inversiones’’, asegura candidata presidencial.


DE BASURA
Botellas, latas, plásticos y demás desechos permanecen a la orilla del mar



RECONOCE NAHLE A EJÉRCITO DE LA SALUD

Editorial: Lic. Julia Méndez Campos
General: Lic. Francisco Sánchez Macías | elheraldodetuxpan.com.mx | | SÁBADO 23 DE MARZO DE 2024 | AÑO XX No 6101 $9.00 G R U P O E D I T O R I A L DE VERACRUZ INTERNACIONAL · PAG 18 NACIONAL · PAG 2 ESTADO · PAG 7 TUXPAN · PAG 3 TUXPAN · PAG 5 TUXPAN · PAG 4
Directora
Director
Se trabajará por otorgarles mejores condiciones a quienes lo integran.
PROTESTAN CAMPESINOS CONTRA EL TRIBUNAL PLAYA, LLENA
BACTERIA CARNÍVORA SE EXTIENDE
»
San Pedro Garza García, Nuevo León.- Tomar decisiones por consenso con empresarias y empresarios de México; generar cadenas de valor a través de la consolidación de corredores industriales en los que se garanticen el bienestar y acceso a servicios de las y los trabajadores, así como continuar con el incremento al salario mínimo y localizar las industrias de acuerdo a los recursos naturales de cada región, son parte de la visión para el desarrollo del segundo piso de la 4T, expuso Claudia Sheinbaum Pardo, candidata a la Presidencia de México por la Coalición “Sigamos Haciendo Historia” (Morena-PT-PVEM) quien se reunió con empresarios y representantes de las cámaras empresariales en Nuevo León, a quienes compartió su visión de un México próspero.
’’Hay una enorme oportunidad de generar polos de desarrollo en el país que nos permitan atraer inversiones, generar infraestructura, pero que además, que en esos lugares se invierta en vivienda, en educación, en acceso a la salud’’, compartió.
Además, destacó que para seguir construyendo bienestar, es necesario que el salario mínimo llegue a 2.5 canastas básicas mensuales, esto en consenso con las y los empresarios de México.
“Nosotros creemos que el salario mínimo debe llegar a representar (…) lo hemos consultado con expertos, debe llegar a 2.5 canastas básicas mensuales, se ha demostrado que el que se aumente el salario mínimo, no necesariamente hay inflación y que si aumenta el salario mínimo no cae la inversión privada, al contrario, lo que se genera es bienestar, y al final por eso la presentación se llama Prosperidad Compartida, por lo que estamos buscando no solamente es crecimiento del PIB, Inversión Extranjera Directa y los grandes indicadores macroeconómicos, sino el bienestar
Expone Sheinbaum visión de desarrollo para el país
“Hay una enorme oportunidad de generar polos de desarrollo que nos permita atraer inversiones’’, aseguró

de las mexicanas y mexicanos”, manifestó.
Recordó que estas decisiones nunca se han tomado de manera unilateral, sino que el gobierno de la 4T ha privilegiado el diálogo constante con el sector empresarial para impulsar políticas como el aumento al salario mínimo, la eliminación del outsourcing, o la estabilización del precio del gas natural.
“Esto evidentemente no va a ser una política de definición desde el gobierno, sino como se ha hecho hasta ahora, en una negociación permanente con los empresarios de nuestro país, aun cuando se habla de polarización, si ustedes se fijan, las decisiones más importantes de nuestro país en materia económica se han tomado por consenso. No ha habido una decisión de aumentar el
salario mínimo de manera unilateral, ha sido una decisión colectiva, por consenso”, precisó.
En el encuentro Claudia Sheinbaum presentó su Proyecto de Nación y visión del desarrollo económico del país, que implica la planeación para la redistribución de empresas con base en vocaciones territoriales y condiciones de cada región del país.
“Necesitamos tener un esquema de planeación, a partir de vocaciones territoriales, de recursos naturales territoriales, es decir, donde hay agua habrá cierto tipo de industrias, donde hay escasez habrá otro tipo y qué infraestructura tenemos que crear en cada una de estas zonas”, explicó.
Asimismo, expuso algunos de los logros más importantes de cuando

fue Jefa de Gobierno en la Ciudad de México, entre los que destaca la reducción de los delitos y de la percepción de inseguridad, la inversión en movilidad, los resultados en transparencia, la atracción de inversión extranjera, el crecimiento económico y la reducción de la pobreza.
Por su parte, Fernando Canales Stelzer, presidente de CANACO Monterrey, reconoció la asistencia de la candidata de Morena, PT y PVEM para sostener un diálogo que permita la construcción conjunta de un mejor país, de cara al proceso electoral que se avecina.
“Este año, en 2024, nuestro país enfrenta la jornada democrática más importante de su historia, no solo por la cantidad de servidores
públicos que serán electos, sino también por ser el padrón electoral más grande de nuestra historia, aunado al significado que tiene para el futuro de nuestro país”, comentó. En la mesa principal estuvieron Gabriel Chapa Muñoz, presidente de COPARMEX Nuevo León y Grupo ICONN; Jaime Herrera, vicepresidente CANACO y director de Key Química; Fernando Turrent, presidente de la Asociación Nacional de Empresarios Independientes; Altagracia Gómez, coordinadora del eje Desarrollo con Bienestar y Perspectiva Regional; Tatiana Clouthier, coordinadora de Voceros de la Candidata; Roberta Clariond Rangel, del Observatorio para la Calidad del Aire.
Deteriorada, ruta de evacuación

No existen las condiciones adecuadas ante una emergencia, en Laguna Verde
AGENCIAS
VERACRUZ
El Ecologista Universal cumplió 39 años haciendo activismo ambiental, realizando un Viacrucis desde la Catedral Metropolitana de Xalapa hasta la planta nuclear de Laguna Verde. Recordó que incluso durante la pandemia del coronavirus efectuó el recorrido hasta la localidad Palma Sola, municipio de Alto Lucero, en la zona costera central del estado de Veracruz. Consideró que las rutas de evacuación del Plan de Emergencia
Radiológico Externo (PERE) en el perímetro de los 60 kilómetros a la redonda de la Central Nuclear de Laguna Verde (CNLV) están en malas condiciones y que, incluso, la gente ni conoce dicho programa.
“Cuando nos dirigimos a la Comisión Nacional de Derechos Humanos dijeron que iba a haber todo lo que necesitábamos de información, en caso de un accidente ver si es que verdaderamente funciona el plan de emergencia radiológico externo, ver, digamos, en algunos lugares donde en algún momento de que se hubiera dado un accidente pues entrar ahí a algunos lugares que son así especiales para evitar la contaminación”.
El entrevistado criticó la falta de acciones por parte de las autoridades para enfrentar el cambio climático y otras crisis ambientales.
El ambientalista comentó que tampoco se han realizado simulacros en la zona y la gente no está preparada para reaccionar ante una contingencia en la planta nuclear.
Director General
Lic. Francisco Sánchez Macías
Directora Editorial
Lic. Julia Méndez Campos
Sábado 23 de Marz0 de 2024 Primera Sección 2. ESTADO El Heraldo de Tuxpan es una publicación de lunes a sábado. Editor responsable Ing. Eduardo Sánchez Macías. Número de Certificado de Reserva de Derecho al Uso Exclusivo del título 04-2016062417532400-101. Certificado de Licitud de Título: 16764. Certificado de licitud de contenido 16764. Domicilio de la publicación, impreso y distribuido por Editora Sánchez S.A. de C.V., con domicilio en 15 de Septiembre No. 7 Col. La Rivera, Tuxpan, Veracruz. C.P. 92800 TEL. 01 (783) 834 16 73 y 01 (783) 835 58 34. ediciontuxpan@hotmail.com CONTACTO REDACCIÓN diariotuxpublicidad@hotmail.com CONTACTO PUBLICIDAD G R U P O E D I T O R I A L DE VERACRUZ | elheraldodetuxpan.com.mx | Gerente Administrativo Lic. Flor Parrilla Silva
Jefe de Redacción Lic. Misael Leyva Julio Jefe de Información Lic. Teresa de Jesús Blasco Ramírez Jefe de Diseño y Producción LCC Rafael Melgarejo Escudero
AGENCIAS


Augura Tránsito mayor afluencia
Habrá apoyo a conductores y peatones, principalmente en puntos conflictivos
LIZBETH ARGÜELLES
TUXPAN
Tránsito municipal está listo para la titánica labor que van a desempeñar durante el periodo vacacional, donde tendrán la encomienda de apoyar a todos los automovilistas que arriban a este municipio para desplazar-
se a la zona de playa, evitar los congestionamientos, los accidentes y estar muy al pendiente de orientarlos para hacer mejor su trayecto.
Previo a la Semana Santa, los elementos tuvieron varios cursos de capacitación para estar a la vanguardia de las necesidades de la ciudadanía, no solamente
de esta localidad, sino también de todas las personas que visiten este puerto. A temprana hora de este viernes ya se comenzó a sentir la cantidad de personas que están llegando al puerto, por ello los elementos comenzaron a brindar el apoyo en los principales cruceros de la ciudad,

Antorchistas bloquean centro de Xalapa
Por invasión en campo deportivo
JUAN DAVID CASTILLA VERACRUZ
Integrantes del Movimiento Antorchista en Xalapa protestaron y cerraron la calle Juan de la Luz Enríquez en la zona centro de Xalapa, la tarde de este viernes 22 de marzo.
Los quejosos denunciaron un intento de invasión en el campo deportivo de la colonia Ampliación Moctezuma, en la
zona sur de la capital, por parte de unos 70 integrantes de la organización Frente de Defensa Popular (Fredepo).
Mencionaron que han solicitado el apoyo de las autoridades, sin obtener una respuesta favorable.
Los quejosos ya habían amagado con manifestarse en el centro de la capital veracruzana y hacer una cadena humana para pedir la intervención del Gobierno del Estado.
Están preocupados porque podría registrar un conflicto entre los integrantes de ambas organizaciones en la zona sur de la Ciudad de Xalapa.
“Desde que nosotros le informamos al ayuntamiento y le informamos o fuimos a ver el asunto Patrimonio del Estado la primera vez más o menos se han metido ya alrededor de metro y medio, dos metros, más o menos”, increparon.
para evitar embotellamientos y las molestas filas en la hora pico. Los puntos de mayor apoyo serán e incluso la bajada del puente entre las avenidas 16 de septiembre y Cuauhtémoc, en la zona del semáforo del boulevard, en la esquina de la Quinta Zona Naval, el puente de Tampamachoco y en el boule-
Instalan nuevos cestos de basura
Calles de mayor circulación dispondrán de estos recipientes; piden a población hacer adecuado uso de ellos
LIZBETH ARGÜELLES TUXPAN
192 cestos peatonales de basura fueron instalados en el primer cuadro de la ciudad, por indicaciones del gobierno municipal y los cuales van a contribuir a que la ciudad se mantenga limpia y luzca
vard de la playa, para que el tráfico sea constante. Los elementos mencionaron que están listos para llevar este nuevo reto, sabedores de que este año pinta para un número mayor de visitantes, además de las familias Tuxpeñas que están fuera y que aprovechan los periodos vacacionales para salir.
con una mejor imagen.
Por ello la invitación a todos los ciudadanos y turistas a hacer buen uso de estos cestos de basura, con el fin de preservar un Tuxpan limpio, pues este programa de colocación estará complementado con el servicio de recolección de basura que se anunció hace algunas semanas.
Además de la entrega de equipo como uniformes que son indispensables para los trabajadores del departamento, para que puedan cumplir con sus actividades sin ningún contratiempo.
El personal municipal, informó que van a hacer trabajos de instalación en avenidas principales; para que los habitantes de este municipio usen los lugares adecuados, para que tiren la basura en los botes y ellos pasen a recogerla.
Estos nuevos contenedores están fabricados en plástico de alta resistencia, especiales para el uso en exteriores.

Primera Sección Sábado 23 de Marz0 de 2024 .3 LOCAL | elheraldodetuxpan.com.mx |
Prestadores
de servicios hacen el llamado a las autoridades
REDACCIÓN
TUXPAN
Este día inicia oficialmente el periodo vacacional, por lo que en Tuxpan se espera el arribo de una gran cantidad de visitantes, y en ese sentido prestadores de servicios turísticos del área de playa norte, están solicitando el cumplimiento de trabajo por parte de la dirección de Limpia Pública Municipal, toda vez que varios kilómetros de esa zona lucen con basura.
Señalaron que esperan la colocación de contenedores, con el fin de que de forma provisional los visitantes depositen en ellos su basura, en lo que el camión recolector hace su trabajo diario.
Explicaron que el fin de semana anterior que fue puen-
Falla Limpia Pública en la playa

te largo, los bañistas dejaron las playas con botellas y diversos materiales, y hasta este viernes la playa lucía sucia,

por lo que al llegar este fin de semana más turistas, todo se iba a poner peor.
Expresaron los prestadores

Último día de clases genera tráfico
Estudiantes foráneos aprovecharon para regresar a sus ciudades
REDACCIÓN
TUXPAN
Pese a que en muchas escuelas del puerto de Tuxpan iniciaron sus vacaciones desde el jueves 21 de marzo, otras instituciones educativas continuaron con sus actividades estudiantiles hasta el día viernes.
Muchas escuelas, en su mayoría preparatorias y universidades continuaron
realizando sus actividades escolares normales con sus horarios habituales.
De igual manera, muchos estudiantes foráneos acudieron a su último día de clases con su equipaje, pues terminando sus actividades escolares, tomarían camino directo a sus ciudades natales.
Estos hechos generaron un aumento en el tráfico, principalmente en el centro de la ciudad a partir del mediodía.
Asimismo, comenzó la llegada de turistas a la ciudad que se espera vaya en aumento en lo que va del fin de semana.
Por lo anterior las autoridades de vialidad llaman a mantener la calma y a manejar con precaución para evitar accidentes por dichos motivos, ya que desde estos momentos se espera que el tráfico vaya en aumento en diversos puntos del mundo, sobre todo en el primer cuadro de la ciudad, y en dirección a la playa.

de servicios, qué, los días más fuertes serán a partir del jueves de la siguiente semana, y por ello se espera la presencia
Todo listo para el Domingo de Ramos
Se espera gran respuesta de feligreses
LIZBETH ARGÜELLES TUXPAN
LaSantaCatedral,ParroquiasyCapillas de la Diócesis de Tuxpan se encuentran listos para iniciar con la semana santa, que de manera oficial arrancará este 24 de marzo, con el Domingo de Ramos, en donde se llevará a cabo la bendición de las palmas o ramos.
Ese domingo se bendicen las palmas o ramas de olivo, que recuerdan la aclamación del pueblo a Jesús en Jerusalén, en la iglesia organizan la procesión de entrada, con cantos y oraciones propias
del personal de Limpia Pública para dejar en buenas condiciones la zona, así como la colocación de los contenedores, de lo contrario se dará una mala imagen de la zona más visitada en esta temporada.
Comentaron que se notificó de la situación a la dirección en cuestión desde hace varios días, y la respuesta ha sido nula para llevar a cabo la limpieza adecuada de la playa tuxpeña.
Por su parte algunos comercios estarán obsequiando bolsas a los bañistas para que depositen su basura, sin embargo, serán necesarios los contenedores para que dejen la bolsa ahí al retirarse de la zona.
del Domingo de Ramos, se proclama el Evangelio de la Pasión del Señor, según San Mateo, adornan la iglesia con flores y palmas.
Para participar en estas actividades los fieles se preparan con oración y reflexión personal, algunos asisten a los retiros o celebraciones penitenciales que se organizan en la parroquia, por lo que los sacerdotes invitan a la comunidad a participar activamente en las celebraciones que se llevarán a cabo a partir del Domingo de Ramos.
En Catedral la procesión se llevará a cabo a las 11:00 de la mañana, la salida será en el Parque Reforma y para dar vuelta por la calle Zózimo Pérez, boulevard Reyes Heroles, Morelos, Juárez y Garizutieta.
Mientras que los horarios de las misas serán de 7:00, 8:30 y 10:00 de la mañana, así también a las 12:00 del mediodía, 6:00 y 7:30 de la tarde, con el objetivo de que los ciudadanos tengan la oportunidad de acudir en alguno de los horarios programados.

LOCAL Sábado 23 de Marz0 de 2024 4. | elheraldodetuxpan.com.mx | Primera Sección

Aseguran que por ningún motivo abandonarán sus tierras, viviendas y parcelas
»REDACCIÓN


Protestan campesinos contra el Tribunal
Tuxpan.- Por segunda ocasión en lo que va del año, campesinos la comunidad de Aguacate de Vinazco perteneciente a Temapache en el municipio de Álamo, se manifestaron la mañana de este viernes frente a las instalaciones de Tribunal Unitario Agrario número 32 ubicado en Tuxpan, toda vez que dicha instancia sigue con una resolución con orden de ejecución para que los campesinos de ese lugar desalojen sus terrenos y parcelas, debido a que las más de cien hectáreas en disputa, supuestamente tienen un propietario, al cual el Tribunal le está otorgando los derechos tras un juicio, acción en la cual los que se dicen afectados no están de acuerdo.
Fue en el mes de enero cuando se manifestaron por primera vez con pancartas en mano, sin embargo, los compromisos adquiridos en ese día por las autoridades del Tribunal no han sido cumplidas.
Los campesinos aseguran que
por ningún motivo abandonarán sus tierras, viviendas y parcelas, éstas últimas a la espera de la producción de siembra hecha recientemente.
En dicho contexto aseguraron qué, entre 1967 y 1969 recibieron los derechos de posesión de dichas hectáreas por parte primero de las autoridades estatales, y después del Presidente de la República en turno, por lo que consideran injusto que después de tantos años aparezca un supuesto dueño de las tierras

AUMENTAN ROBOS EN TIENDAS
Comienzan de manera chica con productos insignificantes, pero llegan a escalar a grandes cantidades
»REDACCIÓN
Tuxpan.- Trabajadores de diversas tiendas departamentales y supermercados ubicados en el puerto de Tuxpan, reportan el inicio de pequeños hurtos o ‘robos hormigas’ a partir de mediados del mes de marzo.
“Ya había parado esta situación por el fin de las vacaciones decembrinas, pero ahora con la llegada de las vacaciones de Semana Santa están volviendo a ocurrir de manera pequeña”, así lo relató un trabajador de una tienda departamental de la ciudad.
De igual manera, empleados de pequeños y grandes supermercados explican que esta clase de hurtos comienzan de manera chica con productos insignificantes, pero que llegan a escalar a grandes cantidades.
Del mismo modo, señalaron qué, aunque han sido situaciones menores, estas llegan a escalar hasta la temporada decembrina, que es cuando más hurtos sufren y no en menores cantidades.
Manifestaron su molestia ante este tipo de situaciones, ya que, hay ocasiones en las que ellos mismos deben reponer los productos faltantes de sus bolsillos.
Por lo anterior se le invita a la ciudadanía tuxpeña a reportar cuando presencien este tipo de actos delictivos que, aunque sean menores, no son correctos.
a querer quitárselas, y lo peor que el Tribunal Unitario Agrario que debería de protegerlos, se les ha puesto en contra al dar la resolución a favor del particular que ahora pretende desalojarlos y dejarlos sin nada, queriendo quedarse con las parcelas ya trabajadas. Ante tal situación esperan ser escuchados y atendidos por la persona responsable del Tribunal Agrario de Tuxpan, con el fin de establecer acuerdos que se cum-
Ritual de Tumilco superó expectativas Esperan turismo durante las vacaciones
LIZBETH ARGÜELLES TUXPAN
El Ritual de Inciensos obtuvo una excelente respuesta por parte de los ciudadanos que visitaron la comunidad para participar en las diversas actividades que fueron programadas, para rendir tributo a la madre tierra por la producción dada y por las nuevas cosechas de este año.
El responsable cultural de las actividades, Salvador Cruz, informó que el ritual fue todo un éxito, que hubo muy buena afluencia, inclusive mayor a la del
plan y dialogar para encontrar una solución que no perjudique a los campesinos y a sus familias.
Remarcaron lo manifestantes que no se saldrán de sus tierras, y enfrentarán cualquier medida que les quieran aplicar, ya que se trata de defender su patrimonio y su fuente de empleo, con la que han mantenido a sus familias durante décadas, y en ese tener esperan el apoyo de las autoridades correspondientes.
año pasado.
Dijo que este año se registró un aumento significativo en la asistencia, lo que demuestra el creciente interés por esta tradición ancestral, por ello el ritual se extendió por cuatro días, del 18 al 21 de marzo, e incluyó una variedad de actividades, como limpiezas de purificación, ofrendas a la Madre Tierra, talleres, danzas tradicionales y música prehispánica.
El momento cumbre del evento fue la ceremonia del Equinoccio de Primavera en el Cerro del Farallón, donde los participantes se unieron en un ambiente de paz y armonía para recibir la nueva estación.
Explicó que el Ritual de Inciensos también sirvió como plataforma para promover la cultura y tradiciones de la región, incluyendo la lengua totonaca, al ser un evento enriquecedor que permitió a los participantes conectar con sus raíces, celebrar la primavera y agradecer a la Madre Tierra por sus bondades.

| elheraldodetuxpan.com.mx | Sábado 23 de Marz0 de 2024 .5 LOCAL Primera Sección
Se realizó reforestación y talleres ambientales
AGENCIAS
TIHUATLÁN
El 21 de marzo, por iniciativa de la Organización de las Naciones Unidas, se conmemora a los bosques del mundo, por ello este día la regiduría cuarta a través de la dirección de Medio Ambiente, organizó actividades relacionadas para crear conciencia en la población en general.
El responsable del área, Mario Abram Salas Aquino, dijo que para esto se realizó la reforestación y talleres ambientales en el Ejido Zacate Colorado; gracias a la participación de los catedráticos y alumnos de la Universidad Politécnica de Huatusco, así como alumnas de agronomía de la UV, sin duda se logra inculcar en menores y jóvenes lo importante que es el cuidado del medio ambiente.
“Los bosques juegan un rol principal en la vida de los seres humanos, suministran alimentos,
Fomentan cuidado de los bosques

agua limpia, salvaguardan la biodiversidad, actúan como un amortiguador contra el cambio climático, ofrecen alimentos, vivienda y empleo para millones de personas
alrededor del mundo, y brindan aire puro”, mencionó.
Finalmente comentó que se debe establecer estrategias para compartir con la sociedad en su

Continúan los trabajos de desbroce y limpieza
»AGENCIAS
Poza Rica.- En un esfuerzo por prevenir la concentración de fauna nociva en zonas urbanas, los trabajos de desbroce de maleza y limpieza general continúan en distintos puntos de la ciudad. Una de las áreas intervenidas ha sido la Avenida Papantla, en la colonia Arroyo del Maíz, donde estas acciones buscan garantizar espacios más seguros y limpios para la comunidad.
La limpieza de terrenos urbanos es una medida preventiva crucial para evitar la proliferación de fauna nociva y mantener un entorno saludable para los residentes.
Autoridades municipales subrayaron que estás labores incluyen el desbroce de maleza y la eliminación de vegetación no deseada, contribuyendo a la seguridad y salubridad de las zonas urbanas.
La legislación reguladora de la limpieza de terrenos establece pautas para el mantenimiento de espacios urbanos, enfocándose en la eliminación de vegetación no deseada que pueda representar un riesgo para la salud pública. Estas medidas buscan garantizar entornos limpios y seguros para la comunidad.
Los trabajos de desbroce y limpieza en zonas urbanas son fundamentales para prevenir la invasión de malezas y la concentración de fauna nociva, contribuyendo así a la preservación de la salud pública y al bienestar de los habitantes de la ciudad.
La limpieza y desbroce de terrenos urbanos son acciones esenciales para mantener espacios seguros y libres de riesgos para la comunidad. Estas labores continúan siendo prioritarias en distintos puntos de la ciudad, demostrando el compromiso con la salud y el bienestar de los ciudadanos.

conjunto una reflexión sobre el gran valor que los bosques representan no solamente en el paisaje sino en el de la salud y el equilibrio de los ecosistemas, ya que no
Dan a conocer Ley Indígena en Veracruz
De ella emana el respaldo que se le da a los pueblos originarios
»AGENCIAS
Papantla.- En las instalaciones del parque ecológico Kiwikgolo, se llevó a cabo un encuentro con los representantes de los pueblos originarios, para dar a conocer la Ley Indígena en Veracruz, sus bondades y alcances, en este municipio se realizó ya que es uno de los principales impulsores de hacer valer los derechos del pueblo totonaca.
Se informó que para que quedara aprobada esta Ley, se hizo una consulta por varios municipios de la entidad, como Tantoyuca, Benito Juárez, Ixhuatlán de Madero, Papantla, entre otros más, para consultar una iniciativa de Ley y reformar el artículo Quinto de la Constitución de Veracruz, pero se tenía que consultar a los pueblos originarios, en cada sede se eligió a un representante, para que estuviera con los legisladores en el congreso y así dictaminar los acuerdos que se realizaron en los encuentros.
A los abuelos del Consejo de Ancianos de Sabiduría Ancestral del Totonacapan, se les explicó de que trata la Ley Indígena de Veracruz, ya que de ahí emana el respaldo
solo son fábricas de agua, hogar de miles de especies y un termómetro de los ciclos climáticos sino también representan una oportunidad económica.
que se le da a los pueblos originarios.
Cabe mencionar que la Ley Indígena en Veracruz, apoya a los pueblos originarios y fue aprobada por el Congreso de Veracruz y debe ser conocida por todos, que sepan de sus alcances y bondades para hacerla valer en cuanto se refiere a usos, costumbres y libre determinación, entre otros aspectos importantes que contempla.
En teoría, dicha Ley ve al indígena como sujeto de derecho para que reciba beneficios que le permitan crecer para lograr su desarrollo y el de sus pueblos, en resumen, las instituciones de gobierno deben destinar recursos y atender las necesidades de los veracruzanos, pero en especial y en un plano diferente a los originarios. Evitar que sean extraños en su propia tierra.
Bonifacio Castillo Cruz, admitió que pese a que los derechos lingüísticos fueron reconocidos hace más de veinte años, “nuestros hermanos siguen en espera de que sus derechos contenidos en el Artículo 5° de la Constitución del Estado, y 2° de la Carta Magna, sean respetados, pero, además, les cambie su forma de vida”.
El legislador local expresó que se debe luchar con la ley en la mano “para evitar que nos sigan dando gato por liebre”. Este día se otorgó una amplia explicación sobre el tema que en verdad interesa a los integrantes de la Cultura Tutunakú. Es importante mencionar que, para llegar a esa Reforma, se realizó una consulta a los pueblos originarios de todo el estado, para cumplir con los requisitos indispensables en esa lucha.

Sábado 23 de Marz0 de 2024 | elheraldodetuxpan.com.mx | 6. POZA RICA Primera Sección

Se trabajará por otorgarles mejores condiciones a quienes lo integran
REDACCIÓN
TUXPAN
En el marco del Foro “Juntos por la transformación de Veracruz”, la Ingeniera Rocío Nahle García reconoció el valor del “ejército médico” que integrado por especialistas mexicanos hizo frente a la pandemia por COVID-19.
Expresó que lo más importante con lo que un ser humano puede


Reconoce Nahle a ejército de la salud
contar es con su integridad física intacta, gracias a ello puede realizar las tareas básicas, además de obtener un sustento y disfrutar de su vida personal y de su familia. Recordó que el sector salud es uno de los que registran aún pendientes y reconoció que aunque se ha avanzado mucho todavía se debe trabajar por otorgarles
mejores condiciones a quienes lo integran.
Expresó que México tiene uno de los mejores servicios de salud de América Latina y el mundo, hecho que se pudo constatar durante la pasada emergencia sanitaria.
Aquí, donde saludó a empleados sindicalizados del área de la salud, Rocío Nahle manifestó que
“en salud no nos sobra nada”, sin embargo hay que atender pendientes. Tras el COVID, puntualizó, el rezago en educación y salud fue palpable “le ha avanzado mucho este gobierno, si, y se hubiera podido avanzar más en este sector pero no se hizo porque se nos atravesó la pandemia, en este y en educación
porque si se pudo avanzar a través de estas clases en línea pero si hubo también un rezago”, enfatizó.
Por lo anterior, destacó el esfuerzo invaluable del personal médico y servicios de salud “en salud todo se canalizó casi por dos años en la pandemia, así tenía que ser pero se sigue y se seguirá trabajando”, subrayó.

Sábado 23 de Marz0 de 2024 .7 ESTADO | elheraldodetuxpan.com.mx | Primera Sección
LLAMAN A ERRADICAR VIOLENCIA POLÍTICA
Convoca diputada a un esfuerzo colectivo y a una actuación efectiva de las instituciones a largo plazo y en el presente proceso electoral
AGENCIAS
XALAPA
La diputada Arianna Guadalupe Ángeles Aguirre se pronunció, durante la cuarta sesión del primer receso de este año, sobre la necesidad de proteger los derechos político-electorales y promover una cultura de paz en Veracruz.
Ante la Diputación Permanente, dijo rechazar y condenar el uso y abuso del poder público mediante conductas arbitrarias e intimidatorias que agredan, atenten, amenacen la integridad de cualquier persona en Veracruz.
Propuso que este Congreso llame a la Secretaría de Seguridad Pública estatal para que comparezca ante esta Soberanía y destacó la importancia de revisar y ajustar los protocolos de la misma Secretaría con enfoque al respeto a los derechos humanos y la prevención de delitos, para que la seguridad pública refleje protección, prevención y garantía de libertades.
También convocó a esta Legislatura a exhortar a la Fiscalía General del Estado y a los órganos competentes a asegurar que toda denuncia de violencia política sea investigada con exhaustividad, imparcialidad y rapidez, garantizando

justicia pronta y expedita.
Además, que el Poder Judicial de Veracruz proceda con la máxima diligencia y transparencia en el procesamiento de los casos relacionados con violencia política y agravios contra los derechos políticos y electorales.
La Diputada indicó que corresponde al Congreso del Estado fortalecer y hacer más eficaz el marco normativo que rige y sanciona la violencia política
y la violencia política debido a género y fortalecer el blindaje de este proceso electoral contra la coacción, la violencia y el miedo.
Por último, destacó la importancia de que los partidos políticos asuman un Acuerdo por la legalidad, la paz y la democracia en el desarrollo del presente itinerario comicial, “lejos de la violencia política que solo destruye, confronta y divide”.

Celebran instauración del Día nacional sin nosotras
Es un día para reflexionar sobre los avances en materia de igualdad sustantiva y la prevención de la violencia feminicida
»AGENCIAS
Xalapa.- En el marco del Día Nacional sin Nosotras (9 de marzo), la diputada Maribel Ramírez Topete se pronunció por consolidar la lucha de las mujeres por la igualdad sustantiva y recordó los hechos históricos, a nivel mundial, que dieron como resultado los derechos adquiridos por las mujeres, los cuales se materializaron con el reconocimiento de la Organización de las Naciones Unidas (ONU) en 1975.
En la cuarta sesión ordinaria, la legisladora subrayó que actualmente cada 8 de marzo se conmemora el Día Internacional de la Mujer, siendo una fecha en la que ya no solo se pide igualdad laboral, “ahora exigimos que se establezcan las condiciones que nos permitan vivir en una igualdad sustantiva”, agregó.
Puntualizó que a esta conmemoración se han sumado colectivos y movimientos feministas para hacer un llamado a las autoridades para que generen políticas públicas que favorezcan un entorno libre de violencia feminicida, seguridad para las mujeres y condiciones idóneas para un desarrollo pleno. A partir de estas voces, indicó, la Cámara de Diputados del Congreso de la Unión aprobó el pasado 27 de febrero el dictamen que declara el 9 de marzo como Día Nacional sin Nosotras, cuyo objetivo es visibilizar la importancia de las mujeres en la sociedad, la lucha contra la violencia sistémica a la que se encuentran expuestas y las condiciones de desigualdad en la que viven.
Aseveró que, con esta acción, el Congreso de la Unión retomó la relevancia que tiene la mujer dentro de los diversos espacios y lo necesario que es, no solo en la creación de condiciones que posibiliten la igualdad sustantiva, sino también en la lucha por vivir en un ambiente libre de violencia.
Asimismo, se pronunció a favor de reconocer el Día Nacional sin Nosotras, como una fecha para reflexionar en los avances que Veracruz ha tenido en materia de igualdad sustantiva y en la prevención de la violencia feminicida.
Finalmente, hizo un llamado a autoridades estatales y municipales a construir una agenda feminista que permita refrendar el compromiso de garantizar a las mujeres espacios libres y seguros, además de generar las condiciones que permitan que en Veracruz se viva en igualdad y libre de violencia.
Apagón, cortan servicio a casas y negocios

No les entregan los recibos a tiempo, para que paguen reconexión
AGENCIAS XALAPA
Más de 20 casas y negocios se quedaron sin servicio de energía eléctrica en la zona sur de la ciudad de Xalapa.
Esto ocurrió en la colonia El Olmo, específicamente sobre la avenida principal que lleva el mismo nombre.
Sin embargo, los vecinos aseguraron que el personal de la Comisión Federal de Electricidad (CFE) no entregó el recibo correspondiente.
Por tal motivo, los usuarios se confiaron en que todavía no les tocaba realizar el pago de su servicio.
Algunas carnicerías, negocios para la venta de materiales de construcción y varias viviendas se quedaron sin el servicio.
Los pobladores creen que podría tratarse de una estrategia por parte de CFE para recaudar fondos mediante las cuotas impuestas para la reconexión de la luz.
La gente confirmó que la suspensión del servicio se realizó por la falta del pago correspondiente.
| elheraldodetuxpan.com.mx | ESTADO Sábado 23 de Marz0 de 2024 8. Primera Sección
Víctima de violencia vicaria en Veracruz
AGENCIAS VERACRUZ
Elisa María Zaldívar Barcelata, víctima de violencia vicaria, denunció que la audiencia programada el jueves 21 de marzo, para la restitución de sus hijos, fue postergada para el próximo 2 de abril.
Ella lucha por la custodia de sus hijos y busca reencontrarse con sus pequeños Kin y León. Elisa esperó tres años para la celebración de una audiencia, en busca de justicia en el caso, pero ésta ha sido muy lenta.
La audiencia estaba programada para el jueves 21 de marzo, a las 14:00 horas, en el Centro de Justicia Penal Oral, ubicado sobre la avenida Jiménez Sur y prolongación Cuauhtémoc, en la colonia Vistamar del puerto de Veracruz.
“La audiencia no se llevó a cabo porque la fiscal no se presentó. Le mandaron un oficio
Postergan audiencia de Elisa Zaldívar

diciendo que no se presentara, que acudiera a otra audiencia. Y que no se presentara, que acudiera a la otra. Entonces, pues, se cambió para el 2 de abril”, detalló.
La tarde del jueves, Elisa se manifestó de manera pacífi-
ca afuera de la Ciudad Judicial junto a más mujeres para exigir justicia en su caso.
En el lugar recordó que tuvo que cambiar su lugar de residencia a Quintana Roo, tras las amenazas de muerte y agresiones por parte de su expareja Juan

MÁS DE 40 SINDICATOS PARTICIPARÁN EN DESFILE
Se organizan para conmemorar el Día del Trabajo
AGENCIAS
XALAPA
Se espera la participación de más de 40 organizaciones sindicales que participen en el desfile conmemorativo al Día del Trabajo el próximo 1 de mayo, informó Pablo Jiménez Ayala, presidente de Organización VIVE.
En conferencia de prensa, recordó que este 2024 se cumplen ya 25 años con la realización de este desfile y se espera
la participación de organizaciones de trabajadores de la construcción, músicos, académicos, burócratas, maestros, entre otros.
En ese sentido, señaló que han solicitado a las autoridades estatales que se garanticen todas las condiciones de seguridad.
“Les pedimos que garanticen el orden, el respeto y tranquilidad de quienes asisten al desfile”, dijo el dirigente del VIVE.
Por su parte, la secretaria general de Federación de Sindicatos la región Xalapa de la CROC, Olga Morales del Valle aseguró que ella logística ya está lista.
Asimismo, sostuvo que siguen recibiendo solicitudes para participar en el desfile del 1 de mayo.
“Le pedimos siempre a Gobierno del estado que nos apoye con seguridad pública, tránsito, protección civil, salud por si algunos de los compañeros se sienten mal”, finalizó.

Eugenio “N”, quien amparado por la “violencia institucional” y por el abuso de autoridad de sus familiares. Ellos se desempeñan como servidores públicos en el Poder Judicial y en el Gobierno del Estado de Veracruz, y han influido en el caso contra Elisa.
Defiende AMLO a Rocío Nahle Tras polémica por casa en Boca del Río
»AGENCIAS
Veracruz.- Sin mencionarla, el presidente Andrés Manuel López Obrador, defendió a Rocío Nahle García quien aspira a la gubernatura de Veracruz, luego de que sus opositores denunciaron que no declaró una casa en Boca del Río.
“Esa persona a la que se le quiere hacer el mal por la temporada, ya ven que como está la temporada de la piña, del mango, del chayote, por lo que yo sé y me consta esa persona es honesta y como yo soy de aquí no le voy a desear a mi pueblo que vuelva a pasar lo que ya sufrieron”, indicó.
Desde la mañanera en Coatzacoalcos el ejecutivo federal, respondió al cuestionamiento de los medios de comunicación respecto al polémico tema de propiedades de la ex secretaria de energía.
Pidió a la prensa ir a ver otras casas en Veracruz y vayan de “mirones” con las mansiones en Boca del Río y hasta yates.
Su expareja la mantuvo en prisión por delitos que no cometió y, a pesar de que existe una orden judicial para la restitución de los menores, aún no ha sido acatada. Zaldívar Barcelata estuvo recluida seis meses en el Centro de Readaptación Social de Cancún, estado de Quintana un Roo. El 1 de mayo de 2023 obtuvo su libertad, pero no ha podido reencontrarse con sus hijos.
Elisa María ahora es activista, miembro de diversas colectivas estatales y nacionales en la defensa de los derechos de la libertad de las mujeres. Es vocera del Frente Feminista de Quintana Roo y además, forma parte de la colectiva “Justicia para madres e infancias en el Estado de Veracruz”, entre otras.
“Para que vean lo que son mansiones, haya por Boca del Río, y para que vean lo que son los yates, búsquenle ustedes que son mirones profesionales y van a encontrar que hay departamentos en el extranjero de quienes mal gobernaron Veracruz, no tiene nada que ver con lo electoral, además, tú eres la responsable porque tu preguntaste”, sentenció el presidente.
El presidente López Obrador, recordó que, en 2012 Felipe Calderón Hinojosa, Genaro García Luna y el exgobernador Javier Duarte de Ochoa, incluso mostró una fotografía en la inauguración del reclusorio de Papantla, aunque dijo que ninguno de ellos es candidato o se encuentra en México para que su comentario sea tomado como algo electoral.
En días pasados José Yunes Zorrilla, precandidato al gobierno del estado por parte de la alianza “Fuerza y corazón por Veracruz”, expuso que Rocío Nahle se enriqueció ilícitamente con la construcción de la refinería de Dos Bocas, Tabasco, con lo que adquirió una casa valuada en más de 30 millones de pesos.
Rocío Nahle quien busca convertirse en gobernadora por Morena, le respondió, que la casa es rentada y llamó intrigoso y difamador a Pepe Yunes. Precisó que el arrendamiento lo hizo de una vivienda de 380 metros cuadrados en Boca del Río.

Sábado 23 de Marz0 de 2024 ESTADO .9 | elheraldodetuxpan.com.mx | Primera Sección

Transitar por la CDMX se ha convertido en una experiencia fastidiosa para sus habitantes. Y es que, en una ciudad excedida de personas, automóviles y ruidos, ahora estamos obligados a ver miles de pendones de publicidad electoral para la jefatura de gobierno, colgados en avenidas y espacios públicos. El asunto es molesto y preocupante por tres motivos:
Primero, el gasto y la contaminación que esto genera. De acuerdo con el Instituto Electoral de la Ciudad de México, el límite de gasto de campaña por candidato es de 63.4 millones de pesos, equivalente a 21.1 millones por mes y 704,504 pesos por día. Dicha suma, según la Fundación por el Rescate y Recuperación del Paisaje Urbano, generará 25 toneladas de basura en la CDMX. La colocación de carteles con la imagen de los candidatos es una práctica arcaica e insostenible. Este enfoque no solo resulta ineficaz desde la perspectiva del impacto publicitario, dada la saturación y el desinterés del público, sino que atenta contra el derecho a un medio ambiente sano.
Segundo, como ciudadanos tenemos el derecho a un ambiente libre de basura. La ciudad ha sido invadida por este material superfluo que des-
OPINIÓN
CONTAMINACIÓN ELECTORAL EN LA CDMX
EUNICE RENDON
figura el entorno urbano y contribuye a la acumulación de residuos. Este tipo de campaña política refleja una falta de compromiso social, en un momento en que la crisis ambiental exige acciones drásticas.
Tercero, es increíble que a estas alturas los partidos políticos no entiendan que hay maneras mucho más eficaces de atraer al electorado, que tapizando la ciudad con sus caras. Las poblaciones actuales, cada vez más digitalizadas, responden mejor a interacciones dinámicas. No por ver infinidad de veces el rostro de un candidato en la calle, la gente votará por él; el que pululen carteles de candidatos de partidos opuestos confirma la inutilidad de la estrategia. Resalta el caso de las últimas elecciones en Argentina, donde Milei superó por casi 11.5 puntos a Massa. Más allá del lamentable resultado, llama la atención que días antes de la votación las calles de Buenos Aires estaban plagadas de anuncios a favor del oficialista y no se veía casi ninguno con el rostro de Milei, quien optó por atraer a la juventud mediante las redes sociales.
El uso de plataformas digitales y redes sociales sirve para alcanzar a un público más amplio y diverso,

El 11 de marzo, Elon Musk informó, a través de X, que en menos de una semana liberaría el código abierto de Grok, su ambiente de inteligencia artificial (IA).
Musk efectivamente cumplió su palabra.
Musk, quien de acuerdo con Forbes es el segundo hombre más rico del mundo —fue relegado en febrero del año en curso a la segunda posición por Bernard Arnault— deliberadamente concibió a Grok como un competidor directo de ChatGPT.
La principal ventaja competitiva de Grok radica en su fuente abierta.
De acuerdo con el Diccionario de Oxford, el término “grok” procede de una jerga informática que significa entender en profundidad. La palabra Grok además evoca la comprensión de ideas complejas, entender algo de manera intuitiva.
El formidable desarrollo de la IA ha propiciado un profundo reordenamiento en las prioridades de las llamadas Big Tech.
El lanzamiento de Grok de facto exhibió el sensible atraso que es posible advertir en Alphabet en materia de IA.
de manera directa y personalizada, además de propiciar una interacción bidireccional entre candidatos y ciudadanía. El activismo digital, las iniciativas comunitarias y la promoción de debates públicos son prácticas que fomentan un enfoque más equitativo y menos invasivo, con mayor impacto y sin deteriorar el entorno urbano.
A nivel internacional existen numerosos ejemplos de regulaciones que limitan la propaganda electoral. Por ejemplo, Francia prohibió los carteles de campaña en 1977; Noruega desde 1975; Nueva Zelanda, cuenta con restricciones sobre carteles políticos en lugares públicos desde 1993 y Lituania desde 2009. Asimismo, en México a nivel local en varios estados como Sonora, la normatividad prohíbe el uso de espectaculares y pendones en la propaganda electoral argumentando la contaminación visual.
Las campañas políticas deberían ser espacios en los que partidos y candidatos socializan sus propuestas a través de un diálogo constructivo, y no un escenario reservado a los ataques y la descalificación. La ciudadanía está a la altura de campañas basadas en propuestas concretas
OPINIÓN
y acciones territoriales de mayor esfuerzo, creatividad e impacto.
¿Por qué no acotar los espacios públicos expuestos a la cartelización electoral? ¿Por qué no transformar pequeños espacios públicos y colocar un tipo de promoción más decente que sea la insignia de quien hace este tipo de cambios con los recursos de su campaña impactando ya en la modificación y el espacio de los posibles votantes?
Los legisladores deben contemplar la reforma a la normatividad electoral para prohibir estas prácticas dañinas e inútiles. No basta con regular materiales y sitios en los que se pueden colocar. Asimismo, urge la adopción de métodos de promoción más modernos y sostenibles, pues trascendería la eficacia publicitaria, para orientarse a un compromiso más acorde con los principios de sustentabilidad y bienestar comunitario, cada vez más valorados por la ciudadanía.
La exposición pública de una imagen debería ser solo un símbolo de las ideas que hay detrás de esos rostros; no puede ni debe seguir siendo la forma predilecta de hacer política.
GROK. UN ARIETE DE MUSK EN SU GUERRA CONTRA OPENAI
OCTAVIO ISLAS
Durante un prolongado periodo Google priorizó a la mercadotecnia, la publicidad y las ventas sobre la ingeniería. Ahora está pagando las facturas por haber apostado por ganancias fáciles, relegando a un segundo plano a la innovación y la creatividad.
La nueva apuesta de Google — Google Gema— fue destinada a los desarrolladores. Gemini, otro de sus ambientes de IA, fue concebida para responder a las necesidades de los usuarios finales.
El inventario de errores que ha cometido Google en materia de IA es extenso. A finales de febrero. Prabhakar Raghavan, vicepresidente senior en Google se vio en la necesidad de presentar disculpas públicas por los errores cometidos en la generación de imágenes a través de Gemini.
Google fue señalada por ser demasiado “woke” al fomentar el racismo contra las personas blancas.
En Meta Platforms, Mark Zuckerberg finalmente comprendió la magnitud del error que representó haber afirmado a Meta, su metaverso, como su prioridad.
Zuckerberg tardó en percatarse que Meta Platforms contaba con un extraordinario equipo de expertos y desarrolladores de IA.
Al poco tiempo de recibir el apoyo y reconocimiento de Zuckerberg, los expertos en IA de Meta Platforms desplegaron LLaMA2.
Llama2 es una “IA libre”, especializada en generar código fuente, de la cual se afirma obtener mejor rendimiento que ChatGPT-4, pues no solo permite ser descargada y ejecutada en el equipo del usuario; además cuenta con 70.000 millones de parámetros.
Sin embargo, Grok supera a LLaMA2 en el número de parámetros, pues dispone de 314.000 millones de parámetros; es decir, es más de 4 veces superior.
Abrir el código de Grok representa un desafío directo a OpenAI.
Elon Musk no solo se ha convertido en el principal detractor de OpenAI y Sam Altman al haber denunciado ante tribunales que la firma responsable del desarrollo de ChatGPT apostó por el lucro, abandonando su misión original.
En primera instancia, Grok será
accesible a los miembros de X Premium+. De esa forma Musk pretende establecer un atractivo incentivo para los usuarios de su sistema de microblogueo, como a todos aquellos interesados en encontrar soluciones de IA en fuente abierta.
Grok es un modelo abierto y gratuito para investigar —como debió ocurrir con OpenAI según lo dispuesto en su misión—. Sin embargo, el equipo de Musk consideró determinadas limitaciones para su uso comercial. Los desarrolladores deben pagar una comisión para usos masivos.
Un elemento ausente en la información relativa a Grok es el origen de los datos que fueron utilizados para entrenar el modelo.
Invocar la virtud de un sistema de IA que dispone de una fuente abierta es loable, sin duda alguna, pero observar un sospechoso silencio sobre el origen de los datos que fueron utilizados para entrenar el modelo resta credibilidad a los buenos propósitos de Musk, quien ha convertido a su guerra contra OpenAI en una de sus prioridades.
Sábado 23 de Marz0 de 2024 | elheraldodetuxpan.com.mx | 10. OPINIÓN Primera Sección

No sé si lo que está pasando en la frontera entre México y Estados Unidos es una crisis, pero sí definitivamente es un caos. Y esto no augura bien ni para México, ni para Estados Unidos.
Esta semana, la decisión de la Suprema Corte de no detener una ley estatal en Texas que permite que las autoridades estatales deporten a migrantes a México, seguido unas horas después por una decisión de la corte de apelaciones de suspender la implementación de la ley, subraya los peligros.
Si los estados norteamericanos pueden cada uno deportar a migrantes a México, generaría una carga enorme para el gobierno de México que tendría que lidiar con diferentes políticas estatales en cada uno de los cincuenta estados del país vecino. Muy correctamente el gobierno mexicano anunció que no aceptaría deportaciones del gobierno estatal de Texas, sólo del gobierno federal de Estados Unidos, y el tribunal detuvo la implementación de la ley estatal.
Tanto las decisiones de gobiernos estatales como el activismo de los tribunales en Estados Unidos en materia migratoria son dos de las amenazas que existen en la frontera, ya que la falta de políticas consistentes genera confusión y
OPINIÓN
CAOS EN LA FRONTERA
ANDREW SELEE
alienta la migración irregular. Pero la administración Biden también ha sido culpable del caos.
Entendieron demasiado tarde que el volumen de llegadas irregulares en la frontera había rebasado sus capacidades para manejarlos, lo cual resultaba en que la gran mayoría de los que llegan a la frontera logran ser liberados en Estados Unidos para esperar una decisión sobre su caso en un futuro lejano, algo que obviamente alienta más migración irregular.
Trataron de corregirlo en el acuerdo legislativo sobre la frontera hace unas semanas, logrando una propuesta para cambios sensatos al sistema de asilo y mayores recursos para las autoridades federales en la frontera, pero era demasiado tarde. Ya estamos en año electoral y no había posibilidades de que demócratas y republicanos avanzaran juntos legislación seria.
Y el gobierno mexicano tampoco queda sin culpa en el caos. En diciembre, cuando los números de llegadas irregulares en la frontera llegaron a un saldo histórico, el gobierno de Estados Unidos presionó a México cerrando varios pasos fronterizos críticos para el comercio y el tránsito en comunidades del norte del país.

Después del magnífico trabajo que realizaron Javier Díaz y Rodrigo González con el primer evento selectivo para Campeonatos Mundiales junior y Centroamericanos de edades, estos personajes dejaron la Comisión Estabilizadora por decisiones personales.
Y lo hicieron porque no se sintieron a gusto dirigiendo la natación, al grado de que perdieron dinero que tuvo que sacar de su cuenta el licenciado Díaz, para pagar lo que fue el alquiler de la alberca y la organización. Pero eso no ha sido todo.
Después de ese evento, se llevó a cabo el selectivo de Juegos Olímpicos en Monterrey, Nuevo León, con una gran organización.
El tercero fue en Querétaro, con el Campeonato Nacional máster, que —según los participantes— fue algo nunca visto, debido a la organización. Un evento con casi mil competidores, liderado por el segundo personaje nombrado por el COM y la World Aquatics para estar al frente de la natación en la Comisión Estabilizadora: Manuel Sotomayor.
Tras esta competencia, se logró hacer también el Campeonato Nacional de categorías y primera fuerza, otra vez en Nuevo León, con
Dieron un golpe duro a las industrias manufactureras en ambos países para mostrar su enojo por la falta de cooperación del gobierno mexicano en contener por lo menos un poco del tránsito de migrantes por territorio mexicano. Hubo una respuesta rápida de las autoridades federales mexicanas a esto, y se aumentaron los esfuerzos de control en México.
No hay soluciones fáciles a la migración irregular hacia la frontera compartida. Hay necesidades apremiantes para trabajadores extranjeros en el mercado laboral de Estados Unidos, sin las vías legales para que estos trabajadores lleguen de forma regular. El Tapón del Darién, un lugar inhóspito entre Colombia y Panamá, que por décadas era una barrera natural a la migración, ya tiene toda una infraestructura para que los migrantes lo pueden cruzar con guías, lo cual abre las posibilidades de migración hacia Estados Unidos a personas viviendo en Sudamérica —y a cualquier persona que puede tomar un avión a Sudamérica de cualquier parte del mundo. Y las crisis de desplazamiento en el mundo, incluyendo situaciones críticas en Venezuela, Nicaragua y Haiti en este hemisferio, son otro factor que dispara la movilidad
participación de mil 600 deportistas, pese a que la federación organizó un evento simultáneo en Colima. Hay que recordar que lo mismo hicieron con el Campeonato Nacional máster, cuando convocaron a un torneo alterno en Aguascalientes, pero fue un fracaso.
No se entiende cuál es la idea de la gente que dirige la Comisión Estabilizadora. No se entiende por qué razón no están satisfechos y hay tantos cambios, en lo que a natación se refiere, cuando desde que apareció ha habido los mejores resultados, con lo logrado en los pasados Juegos Centroamericanos y Panamericanos.
Es increíble que los mejores nadadores mexicanos juveniles e infantiles tengan que sufrir un desgaste económico, porque primero te programan un selectivo para Juegos Conade en Guadalajara, para el que los padres de familia tienen que poner dinero. Después, obligan a ir a un selectivo para Campeonatos Centroamericanos de edades en Puerto Vallarta; luego, te exigen ir a Monterrey al de los Juegos Centroamericanos, donde tendrás que pagar tu hospedaje, transportación y alimentación.
Qué padre aguanta —en menos de mes y medio— hasta seis eventos, con un costo elevado
hacia el norte.
En un mundo de disparidades económicas, crisis económicas y políticas y avances exponenciales en transporte y comunicación, no hay vuelta de hoja. Habrá mucha migración, y será a veces impredecible. El tema es cómo evitar que esta migración lleve al caos. Porque el caos, sobre todo en la frontera México-Estados Unidos, provoca efectos secundarios nocivos. En Estados Unidos, ha contribuido a un creciente rechazo a los migrantes, sobre todo los recién llegados, y alienta a los demagogos que prometen cerrar la frontera. Lo de la administración Biden en diciembre fue un preludio light de esto, pero que podría ser mucho más extendido y destructivo si llega Donald Trump a la presidencia o si Joe Biden se siente acorralado políticamente por el tema migratorio.
La única forma efectiva de manejar la migración irregular es combinar los esfuerzos de control con la apertura de mayores vías legales para la migración y mecanismos de protección humanitaria más ágiles, pero también requeriría que líderes en México y Estados Unidos tomen en serio las consecuencias del caos y buscar evitarlo. A final de cuentas, hay un interés mutuo que habría que reconocer.
de transporte, hospedaje y comidas, para representar a México. Se necesitaría ser millonario, cuando ese debe ser el trabajo de planeación de la gente que se queda en la Comisión Estabilizadora, y nadie levanta la mano, porque los padres —con tal de que sus hijos asistan— empeñan hasta la camisa.
Pareciera que lo que buscan todos es que la gente que está en la natación no tenga éxito. Lo mejor, como ya lo he dicho, sería que cada disciplina acuática tenga su federación, pero tal parece que hacer bien las cosas no preocupa a nadie. De los dirigentes del deporte mexicano, cada uno lleva su agenda. Digo que nos la volvieron a aplicar porque la semana pasada, el licenciado Sotomayor renunció a la Comisión Estabilizadora, por falta de apoyo.
En lo que respecta a Selecciones Nacionales Mayores, no tenemos problemas, pero falta mucho por desarrollar en infantiles y juveniles, porque no se ha podido hacer mucho. Aparentemente, vamos bien, pero falta lo más importante: La planeación de un ciclo olímpico completo y las elecciones para hacer una nueva federación.
Sábado 23 de Marz0 de 2024 .11 OPINIÓN | elheraldodetuxpan.com.mx | Primera Sección AGUAS CON NELSON COMISIÓN ESTABILIZADORA... NOS LA VOLVIERON A APLICAR NELSON VARGAS
AGENCIAS
MÈXICO
Yolanda llama vulgar a Laura
Yolanda Andrade, famosa conductora mexicana, estalló en contra de la actriz Laura Zapata luego de que varios reporteros le mencionaran que la hermana de Thalía supuestamente aseguró que la enfermedad que padeció hace algunos meses era un “karma”.
La conductora de ‘Montse & Joe’ no se guardó nada y le respondió a la actriz de telenovelas asegurando que era una “corrientita” y “vulgar” por hablar así de su estado de salud. Esto fue lo que dijo.
Yolanda Andrade compartió en entrevista con varios medios de comunicación su opinión sobre las recientes. Declaraciones de Laura Zapata acerca de un supuesto romance entre su hermana Thalía y el productor de telenovelas recientemente fallecido, Nicandro Díaz. La conductora de televisión aseguró que ese tipo de comentarios como el que realizó Laura Zapata, no deben realizarse en un momento tan triste como el fallecimiento del productor. Además, le envió un controvertido mensaje a la villana de telenovelas.
Durante la entrevista, varios reporteros le comentaron a Yolanda Andrade que Laura Zapata, habría mencionado que la enfermedad que padeció la conductora se la

merecía, pues era un karma.
Tras enterarse de lo que los reporteros le mencionaron, Yolanda Andrade estalló contra Laura Zapata a quien tachó de corriente y vulgar y realizó comentarios sobre la madre de la actriz.
Yolanda Andrade aseguró que Laura Zapata era una persona “más corriente” que ella.
¿Qué dijo Laura Zapata sobre Yolanda Andrade?
En un video compartido por la reportera Berenice Ortiz, la hermana de Thalía y villana de telenovelas
respondió acerca de los cuestionamientos sobre el estado de salud de Yolanda Andrade.
De acuerdo a las declaraciones de Laura Zapata ella desconocía detalles de lo que le pasó a Yolanda, pero explicó que cuando lanzas un bumerán éste se te regresa “a cortarte la cabeza”.
La polémica surgió cuando la actriz respondió una de las preguntas de los reporteros que le cuestionaron sobre los comentarios de qué si Verónica Castro en la vida hecho brujería a Yolanda Andrade
Madre de Maribel vence el cáncer
AGENCIAS MÈXICO
Maribel Guardia, quien sigue demostrando su dolor tras sufrir la pérdida de su hijo
Julián Figueroa, en esta ocasión compartió una gran noticia y es que ‘su mamá’ logró vencer el cáncer, enfermedad que le fue diagnosticada hace hace casi año y medio
A través de redes sociales, Maribel Guardia compartió el emotivo momento junto a un mensaje que da esperanza a todas aquellas personas que también sufren esta enfermedad; aquí te contamos qué dijo.

plicada enfermedad.
“Mi mamá venció el cáncer. Celebramos la vida, su fe en Dios, su amor a la virgencita, y a ese espíritu lleno de alegría y positivismo que fueron la cereza en el helado”, dice la primera parte del mensaje compartido por Maribel Guardia.

IA guía película “Marea alta”
AGENCIAS MÈXICO
Hacer una película de ficción, teniendo como herramienta a la Inteligencia Artificial (IA), ya se hizo realidad en México, con una historia que fue filmada en las playas oaxaqueñas y protagonizada por Paulina Gaitán.
“Marea alta”, dirigida por Juan Carlos Blanco, echó mano de la IA para conocer los distintos derroteros que podría tener una secuencia; permitió la visualización de cuadros gracias a su generación de imágenes y hasta se llegó a un actor que físicamente respondía a la propuesta arrojada por la tecnología.
Eso sí, aclara Blanco (La noche del pirata y Cena para tres) que sólo se ocupó como una herramienta para agilizar procesos, porque al final de cuentas, la decisión de la obra recae siempre en el director. Hasta ahora, el uso de la IA en México se había limitado a duplicar la voz de alguien, como en el documental Pola Weiss, donde se recreó la voz de la artista fallecida, y en algún corto de ciencia ficción.
Marea alta es producto de la recién incorporada materia Proyectos Asistidos con IA de INDIe, Centro de Estudios Cinematográficos, del que el cineasta es director y también profesor.
“La idea era demostrar que sí se podía hacer un proyecto y que acortaba procesos. Les decía a los alumnos que no debía tenerse miedo a la IA, que era algo que ya había llegado y que quien sepa manejarla, va a tener ventaja”.
El filme tardó tres meses desde su escritura y hasta su primer corte, es decir, acelerando todo hasta en un 40%, de acuerdo con el creativo. El guión tuvo como origen una noticia que leyó sobre unos turistas argentinos que habían sido agredidos en una playa. A partir de ahí comenzó a imaginar historias y llegó a la de una pareja (Gaitán y Gary Centeno) donde el hombre le propone matrimonio a la chica.
Vilma Chacón, a quien Maribel Guardia considera su mamá en realidad es su hermana mayor, logró superar el cáncer que le fue diag-
nosticado hace 17 meses. Desde una clínica en Costa Rica, la querida actriz mexicana celebró la vida tocando la campana junto a su hermana mayor, o su madre como ella la considera, mandando un mensaje de esperanza a todas las personas que atraviesan esta com-
Agregó: “Si se puede Nada es imposible para Dios. Mil gracias a la unidad de #quimioterapia del Hospital México y al personal médico de la @ ccssdecostarica Dios los bendiga, tratan a los pacientes con un amor infinito”.
En el video también se puede apreciar a Vilman Chacón tocando la campana de la clínica en Costa Rica, celebrando que después de 17 meses ya no corre peligro.
De lo primero que comenzó a escudriñar con la IA fue el look del personaje masculino. Blanco dio instrucciones precisas: la imagen de un hombre de alrededor de 30 años, cabello largo, barba, con ojos claros, que está en la playa y había tenido una pelea.
“Entonces comenzaron a pasar cosas, publiqué la imagen y la actriz Lorena del Castillo, a la que yo no conocía, arrobó a Gary y le pedí me mandara una foto ¡y se parecía muchísimo! De pronto ya tenía al actor”, cuenta.
Además de Gaitán (Diablo guardián) y Centeno (La casa de las flores), en el elenco se encuentran Juan Carlos Colombo (Los enviados), Ignacio Guadalupe (Los Héroes del Norte), Fermín Martínez (Narcos: México) y Yesenia Barajas (La bandida).
| elheraldodetuxpan.com.mx | Primera Sección Sábado 23 de Marzo de 2024 12. ESTILOS
Mujer deberá disculparse con Edgar
AGENCIAS
MÈXICO
Fernando Ariel Tenorio, juez de la Ciudad de México, determinó que Anhelé Sánchez tendrá que disculparse con el cantante Edgar Oceransky, luego de acusarlo de abuso sexual, además de que deberá pagar su terapia psicologica al determinar que hubo daño moral contra el trovador.
Anhelé Sánchez denunció a Oceransky a través de sus redes sociales, por lo que el juez Fernando Tonorio declaró que se cometió daño moral y se “hirieron los sentimientos” del acusado al no presentarse una denuncia penal en su contra. Es por esto que ahora Anhelé
deberá realizar una publicación en sus redes sociales disculpándose públicamente con su supuesto agresor, Edgar Oceransky, “por haberlo calificado de pedófilo abusador de menores”, se reveló en un comunicado compartido por la propia Anhelé.
Además de las disculpas públicas, se deberá pagar el acompañamiento psicológico que el trovador requiera.
“Dice el juez que me tengo que disculpar y pagarle la terapia a mi abusador. La sentencia es totalmente fuera de proporción, carente de perspectiva de género y clase ¿A mí quién me pide perdón?”, escribió Anhelé en su cuenta de X, antes Twitter, citando el comunica-
Destrozan
‘Puntería’, nueva canción de Shakira
AGENCIAS
ESTADOS UNIDOS
La cantante Shakira dio a conocer la totalidad de su nuevo álbum Las Mujeres Ya No Lloran, proyecto que representa para la colombiana una forma de externar sus emociones tras su separación con Gerard Piqué y que tardó casi dos años en crearse por completo.
Tiempo Sin Verte, Cómo Dónde y Cuándo, Cohete, Nassau, remix de Sessions Vol. 53, Última, La Fuerte y Puntería, son las ocho canciones que se unen a temas como Te Felicito y TQG.
Por medio de una entrevista a Apple Music, la intérprete de Monotonía y Copa Vacía externó que con las canciones también representan una forma de curar el dolor que le provocó su separación.
“Nadie va a venir a decirme como debo curarme y nadie debe de decirle a una mujer cómo debe de sanar y lamer sus heridas. Estamos viviendo en otras épocas”.
Internautas critican Puntería, canción de Shakira y Cardi B
Aunque no hay duda de que cada estreno se volverá un éxito en la carrera de Shakira, algunos internautas mostraron su descontento por Puntería, la nueva canción de Shakira en colaboración con Cardi B, reconocida rapera de Estados Unidos.
De acuerdo con algunos internautas el nuevo tema tiene un estilo similar a Tusa, canción de
do compartido por una de las asociaciones que reclama esta sentencia.
¿Por qué Anhelé acusó a Edgar Oceransky?
Anhelé denunció al cantante Edgar Oceransky de violencia sexual, esto luego de que se viralizara un show donde habla sobre menores de edad y causara escándalo entre la comunidad, quienes pidieron cancelarlo.
Posterior a esto, una joven salió a dar testimonio de cómo fue la experiencia que vivió junto al famoso, quien negó rotundamente haber causado daños a su denunciante; hace apenas unos días Oceransky demandó a Anhelé por 4 millones de pesos.

Karol G, por lo que las criticas no se hicieron esperar.
Fue a través de un video de TikTok, compartido por la cuenta @lamusica.pe, en donde se compartió un fragmento del video oficial de Puntería. Ahí se observó a las dos famosas cantar al ritmo de la melodía.
“Ya se encuentra disponible la nueva canción de Shakira junto a Cardi B”, escribió la usuaria de TikTok @lamusica.pe.
Shakira bailó con sus característicos movimientos de cadera y mantuvo una escena con el actor Lucien Laviscount, quien únicamente portaba pantalones claros y el torso lo llevaba desnudo por lo cual lucía su figura atlética.
“Parece más al video de la tusa de Karol G”, escribió una internauta molesta.
Otros internautas comentaron que la combinación de géneros en el nuevo álbum de Shakira no les pareció acorde a la carrera que ha llevado. A continuación te dejamos más críticas al respecto.

Colin Farrell en El Pingüino
AGENCIAS ESTADOS UNIDOS
Max acaba de estrenar el nuevo tráiler de El Pingüino, la nueva serie producida por Warner Bros Television y DC Studios, que se estrenará en la plataforma de streaming Max, antes HBO Max.
La nueva serie, que se agregará al catálogo de Max este año, tiene a Colin Farrell como protagonista, es decir que dará vida al infame Oz Cobb, mejor conocido como El Pingüino.
De acuerdo con la información proporcionada hasta este momento, este nuevo spin-off del éxito taquillero, The Batman, de Matt Reeves, contará con ocho episodios los cuales estarán disponibles en otoño de este año. El nominado al Premio de
la Academia Colin Farrell es #ThePenguin en la nueva serie original de Max, que llegará este otoño a Max”, así presentó Max el nuevo adelanto de su nueva serie.
Además de Farrell, el reparto incluye a Cristin Milioti, Rhenzy Feliz, Michael Kelly, Shohreh Aghdashloo, Deirdre O’Connell, Clancy Brown y Michael Zegen. Aunque Farrell ya demostró sus habilidades como este villano en Gotham City, en la película de The Batman, esta serie promete profundizar mucho más en el trasfondo de su personaje . Los fans de Batman tendrán que disfrutar de los ocho capítulos de esta nueva serie, pues la parte dos de la película protagonizada por Robert Pattinson tiene una fecha de estreno contemplada para el 2026.

| elheraldodetuxpan.com.mx | Primera Sección Sábado 23 de Marzo de 2024 .13 ESTILOS

Memo Ochoa acecha importante marca
AGENCIAS ESTO
Su titularidad en la portería de la Selección Mexicana en el partido ante Panamá de la Concacaf Nations League 2024 fue cuestionada y criticada, pero Guillermo Ochoa se encargó de justificarla una vez más. Con seis atajadas en el partido, cuatro de ellas determinantes, el guardián nacional mantuvo su meta en cero. Sumó una más que lo hizo llegar a un total de 65 porterías imbatibles en su historia con el Tricolor en sus 150 partidos.
De los últimos 10 cotejos que Memo ha disputado con el combinado dirigido por el Jimmy Lozano, el del Salernitana de la Liga Italiana ha colgado el cero en cinco ocasiones, lo cual, lo ha metido a una lista especial entre los porteros qué más veces lo han hecho a nivel de selecciones nacionales. De hecho, se puso a sólo
cinco de entrar al Top-5 de cancerberos con más vallas impenetrables de la historia al máximo nivel.
Si Ochoa repite y mantiene su portería intocable en la final ante Estados Unidos igualará al mítico Peter Shilton, quien sumó un total de 66 metas en 130 partidos con la Selección de Inglaterra, y se colocará en el octavo lugar de la lista al también ya haber superado al francés Hugo Lloris (63).
El cancerbero mexicano tendrá más juegos en este año para empatar y rebasar a tres más como Essam El-Hadary de Egipto, Sayed Jaffer de Bahrein y Mohamed Al-Daeyea de Arabia Saudita, quienes sumaron un total de 69 metas invictas. Será en ese momento cuando entre a los mejores cinco porteros en ese sentido en una lista que lideran leyendas como Iker Casillas (102), Gianluigi Buffon (77) y Edwin Van der Sar (72). Sobre todo, estos últimos dos, quienes lucen

alcanzables para Memo si se mantiene como titular hasta el Mundial 2026.
GUILLERMO OCHOA TENDRÁ OPORTUNIDAD DE ENTRAR A LA SELECTA LISTA
En partidos amistosos es donde más porterías en cero tiene Memo Ochoa con un total de 22. Rivales como Hungría, Venezuela, Angola, Chile, Nueva Zelanda, Nigeria, Paraguay, Escocia, Perú y Ghana se han topado con la figura del portero nacional y no han podido marcarle alguna anotación.
En Clasificación a Mundiales, de los 33 partidos que ha disputado, ha dejado su meta imbatible en 16 de ellos. Costa Rica, Honduras, Estados Unidos y Panamá, como los rivales más fuertes de la zona tampoco pidieron marcarle al mexicano en varios juegos. Lo mismo que en la Copa Oro, que en 25 partidos dejó su portería intocable en 15 ocasiones.
¿Chicharito se volvió a lesionar?
AGENCIAS
ESTO
Javier Hernández no volverá a Los Ángeles. El delantero del Guadalajara es bajo para el amistoso que el club tendrá ante Atlas en California por una molestia en su tobillo. Además de la ausencia de Chicharito, el lateral Alan Mozo tampoco realizará el viaje con el resto del equipo.
ESTO confirmó que Hernández Balcázar no realizó el viaje con el plantel a suelo norteamericano, debido a que el cuerpo médico recomen-
César Montes piensa en la revancha ante EU
AGENCIAS ESTO
César Montes tiene un amargo recuerdo ante Estados Unidos. En el último partido ante los norteamericanos el defensa salió expulsado, lo que al final influyó para que el equipo mexicano perdiera por goleada (0-3) en la semifinal de la Concacaf Nations League 2023.
Ahora al defensa le ha llegado la oportunidad de redimir aquella actuación y nada mejor que ganarle el trofeo al máximo rival de la zona. “En lo personal para mí si es una revancha porque en su momento ofrecí disculpas y reaccioné como no debía. Sí será un lindo encuentro, ahora nos encontramos en la final y será un gran partido para ambas selecciones “, aseguró después de la victoria ante Panamá.
“Critica, presión, siempre va a haber porque la exigencia es máxima estando a nivel selección. Creo que tenemos una bonita rivalidad y una revancha para esta final, queremos hacer historia y queremos lograr grandes cosas como ganar por primera vez este torneo”, añadió. El zaguero tricolor reconoció la fortaleza del equipo de las Barras y las Estrellas, misma que salió a flote en su cotejo ante Jamaica. Montes pidió tener especial atención a la táctica fija para no tener problemas en el juego de este domingo.
“Será un partido muy rudo, con ambas selecciones que proponen para jugar y yo creo que tenemos que estar muy atentos a la pelota parada tanto a favor como en contra porque ellos por esa vía, con un poco de fortuna empatan y se van a tiempos extra. Es una de sus fortalezas, tenemos que estar atentos a eso”, admitió.
CÉSAR MONTES DEFENDIÓ AL JIMMY LOZANO
Previo al partido ante los panameños, el entorno en la Selección Mexicana no fue del todo bueno. Entre que se hablaba de un mal momento del equipo del Jimmy Lozano y hasta una posible destitución del entrenador en caso de que no accediera a la siguiente ronda. Todo eso poco importó en los jugadores.
“Es cuestión de tiempo. No sé por qué se comenta eso que estamos en crisis, que si el técnico se perdía se iba. Yo creo que Lozano está haciendo las cosas bien, el equipo también, son cosas que no nos deben de abrumar, no podemos pensar en esas cosas. Él nos transmite seguridad, confianza y nosotros estamos respondiendo dentro del campo”, finalizó.

dó a Fernando Gago darle descanso durante estos días de parón por la Fecha FIFA y tenerlo en condiciones óptimas para la Jornada 13 en donde visitarán a los Rayados del Monterrey.
Por su parte, Mozo reportó molestias en uno de sus tobillos, motivo por el cual tampoco está considerado para hacer frente a los Rojinegros. A ellos también se suman las ausencias de José Castillo y Mateo Chávez.
La novedad en la lista del técnico argentino es el regreso de Pável Pérez. El extremo rojiblanco volverá a salir al campo -al menos en la banca- después de una larga ausencia. El atacante que se adueñó de la banda derecha en el inicio del Clausura 2024 estuvo ausente desde la Jornada 9. Su última aparición fue contra los Rayos del
Necaxa.
Otro de los elementos que también resaltan es Carlos Cisneros, quien se recuperó al cien por ciento de una rotura de ligamentos en la rodilla derecha en las semifinales del Clausura 2023 contra el América. El ariete se perdió todo el torneo de Apertura y la mitad de la fase regular de este semestre, por lo que deberá aprovechar los minutos que Gago le dé en el campo si es que quiere ser considerado para tener minutos en el torneo local.
Sumado a los regresos de los lesionados, llamó la atención el nombre de Ariel Castro, juvenil de las fuerzas básicas del Rebaño Sagrado que brilló en el Clásico Nacional Sub-23 del fin de semana pasado.
Sábado 23 de Marzo de 2024 14. DEPORTES | elheraldodetuxpan.com.mx |
Santiago Giménez tiene los goles; Henry la confianza de Lozano
AGENCIAS
ESTO
Son los delanteros del momento en la Selección Mexicana. En el último partido ante Panamá de la Concacaf Nations League, el director técnico Jaime Lozano optó por la experiencia de Henry Martín por encima de la mejor productividad de Santiago Giménez a nivel de clubes en la actual temporada.
El futbolista que milita en Europa tiene todo a su favor para ser el delantero titular en el Tricolor, a pesar de su juventud. La efectividad, los goles y las estadísticas ofensivas le dan la ventaja al canterano de Cruz Azul. Incluso por arriba de la Bomba, quien tampoco cuenta con malos números, sin embargo, el más joven ha demostrado estar en mejor momento con todo y su larga sequía en Países Bajos. Santiago Giménez ha marcado 24 goles y dado cinco asistencias en la temporada 2023/24 con el equipo de Róterdam. A pesar de una mala racha de cinco partidos sin marcar en la Eredivisie, el mexicano sigue en la lucha por el
título de goleo con 21 tantos en el torneo local. Sólo dos por debajo de Vangelis Plavidis y uno de Luuk de Jong. Además, el apodado Bebote ha marcado en Champions League y Europa League a rivales como Lazio y Roma.
Henry Martín ha tenido una menor cosecha de celebraciones. Si bien fue campeón con el América en el último torneo como hombre determinante en Liguilla con cinco goles, incluido uno en la final contra Tigres, el atacante yucateco ha marcado únicamente 14 tantos en la temporada. 12 de ellos en la Liga MX, uno en la Leagues Cup ante el St. Louis City y otro ante Chivas en la Concachampions. Es decir, tiene un total de 10 goles menos que su competencia en la zona ofensiva de la Selección Mexicana. Además de que cuenta con seis pases para gol.
Santiago Giménez tiene mejor efectividad que Henry Martín
En lo que respecta a la efectividad, Santiago Giménez también tiene números mejores que Henry Martín. El joven marca cada 116 minutos, sus 24 goles son repartidos en 2,790 minutos mientras que

el más veterano logró sus 14 goles en 1,991 minutos, es decir, un gol cada 142 minutos con el equipo azulcrema.
Al final la jugada le salió a la perfección al Jimmy Lozano. El americanista jugó todo el partido ante los canaleros y dio una asistencia a

Checo Pérez
podría seguir
en Red Bull tras 2024
AGENCIAS
ESTO
El asesor de Red Bull, Helmut Marko, dejó entrever la posibilidad de que Sergio “Checo” Pérez se quedaría en la escudería en caso de que tenga buenos resultados como ha sucedido en las dos primeras carreras de la temporada 2024 de la Fórmula 1.
El tapatío se ubica en el subliderato de pilotos sólo detrás de Max Verstappen, incluso, subió al podio en los Grandes Premios que se realizaron en Baréin y Arabia Saudita.
“En este momento, Sergio está en una muy buena posición… Ha ofrecido dos carreras muy buenas. Es segundo en el campeonato. La pregunta de quién debería reemplazar a Pérez no se plantea realmente”, comentó Marko.
Helmut, un crítico con el desempeño de “Checo” desde que llegó a la escudería, comentó que ningún otro piloto está en el nivel del mexicano, ni los corredores del equipo B Racing Bulls, ni Daniel
Ricciardo quien el año pasado regresó a la categoría y tampoco Yuki Tsunoda.
“Ambos pueden aspirar a un puesto en Red Bull Racing. Uno de ellos tendría que estar muy por delante del otro, pero, en carrera, ambos son demasiado lentos. Creo que un punto habría sido posible en cada una de las dos primeras carreras”, dijo en entrevista para Sky Sports.
¿CUÁNDO ACABA EL CONTRATO DE CHECO
PÉREZ CON RED BULL?
Pérez finaliza contrato con el equipo de la bebida Energizante al concluir la actual temporada y, hasta el momento, ni la escudería ni “Checo” han hablado sobre la posibilidad de renovar.
En diciembre del año pasado, Christian Horner, director de Red Bull, comentó que la permanencia de “Checo” dependía únicamente del desempeño del tapatío.
“El asiento de ‘Checo’ depende de él…Vamos a ver cómo se desarrolla 2024. Pero en gran medida depende de ‘Checo’ más que de explorar otras opciones”, comentó Horner.
Julián Quiñones. Mientras que el de Feyenoord se quedó en el banquillo, con todo y berrinche incluido por no haber tenido minutos en el AT&T Stadium, consciente de que también pudo hacer daño a los canaleros en cualquier momento.
Para la final ante Estados Unidos,
según la costumbre del entrenador, le tocará el turno a Santiago Giménez de ser titular y de esa forma tendrá la oportunidad de demostrar ante el equipo norteamericano que puede ser el hombre gol y total referente al ataque para México.
¿Mbappé se unirá al Real Madrid?
AGENCIAS
ESTO
El atacante y capitán de la selección de Francia Kylian Mbappé hizo algunos comentarios sobre su futuro, aunque se negó a confirmar su marcha del PSG al final de la temporada.
“No he anunciado nada hasta ahora porque no tenía nada que anunciar. Siempre he dicho que el día en el que tenga algo que decir, lo diré. Nunca me he escondido, no tengo miedo. Pero siento decepcionaros, no tengo nada que anunciarles”, explicó el jugador del PSG al ser preguntado sobre su futuro en el fútbol de clubes.
Según una fuente cercana al asunto, Mbappé indicó a principios de febrero a los dirigentes del PSG que no renovará su contrato y dejará el club al término de este en junio, siete años después de llegar a la entidad. El Real Madrid es el grandísimo favorito para hacerse con sus servicios.
“Estamos en el esprint final en todas las competiciones. La idea de lograr un triplete es mucho más importante que la cuestión de saber si voy a quedarme o no. Hay partidos importantes que vienen, estamos concentrados en eso”, aseguró.
Mbappé también fue preguntado sobre su deseo de participar en los Juegos Olímpicos de París este año e insistió en que no es una decisión que dependa de él,
sino más bien del club en el que esté en ese momento.
“Siempre he tenido el mismo deseo, he dicho que los Juegos Olímpicos en París son un evento especial y que quería estar ahí. Siempre he dicho también que no depende de mí. Mi intención no ha cambiado, pero la decisión final no me corresponde a mí. Estoy en un momento de mi vida en el que tomo distancias. Si voy, viviré un sueño. Si no voy, tendré que aceptarlo “, declaró.
El Real Madrid, que según los rumores sería probablemente el destino de Mbappé para la próxima temporada, envió una carta a la Federación Francesa de Fútbol para informarle de que no liberaría a ninguno de sus jugadores extranjeros para los Juegos Olímpicos.

| elheraldodetuxpan.com.mx | Sábado 23 de Marzo de 2024 .15 DEPORTES

Senado garantiza derechos de policías
AGENCIAS
MÈXICO
Con 76 votos unánimes, el pleno del Senado aprobó disposiciones legales para reforzar el derecho de los policías de todas las corporaciones de seguridad pública del país a contar con prestaciones que sean equivalentes a las que tienen los trabajadores del Estado.
El pleno del Senado vivió ayer un ríspido debate por la intención de Morena de quitarles el derecho a la defensa a los policías, lo que generó la crítica de la oposición, incluso la panista Lilly Téllez subió a tribuna a pedir a la población que no olvide que Morena se negó a proteger a los policías, lo que nuevamente generó agresiones en su contra por parte de la morenista Rocío Abreu, quien, desde su escaño, le hacía señas manuales y le lanzaba adjetivos.
Las críticas de la oposición originaron que la morenista Lucía
Trasviña anunciara que retiraba su reserva, pero después Morena rechazó la reserva hecha por el perredista Miguel Ángel Mancera, para añadir beneficios a los cuerpos policiacos.
La reforma, que fue turnada a la Cámara de Diputados, establece que “son derechos de los integrantes de las Instituciones de Seguridad Pública,lossiguientesrecibiruntrato digno y respetuoso de sus superiores jerárquicos, iguales o subalternos y el respeto de la comunidad a la que sirven”.
También “asistir y participar en los cursos de capacitación, actualización, profesionalización y especialización correspondientes, así como en aquellos que se acuerden con otras instituciones académicas nacionales y del extranjero que tengan relación con sus funciones, conforme a la disponibilidad presupuestal y las necesidades del servicio”.
De igual forma, “percibir una

remuneración, de acuerdo con las funciones que desempeña, que determine el presupuesto de egresos correspondiente, así como las demás prestaciones de carácter laboral y económico que se destinen a su favor; gozar de las prestaciones y los servicios en materia de seguridad social, conforme a las disposiciones legales y reglamentarias aplicables”.
Los policías de todos los niveles de gobierno y en todo el país tienen derecho a “recibir el uniforme y demás equipo de cargo reglamentario sin costo alguno en los términos que se establezcan en las normas respectivas; “ser sujeto de promociones, ascensos o reconocimientos”.
Además, a “recibir atención médica oportuna sin costo alguno, cuando sea lesionado en cumplimiento de su deber. En caso de extrema urgencia o gravedad, deberán ser atendidos en la institución de salud más cercana al lugar donde se produjeron los hechos.
Difunden expediente de adeudo de Ricardo
AGENCIAS MÈXICO
Como lo había prometido el pasado miércoles el presidente Andrés Manuel López Obrador, Presidencia de la República difundió documentos del adeudo fiscal de 63 mil millones de pesos que tienen empresas de Ricardo Salinas Pliego.
En ese sitio web también pueden ser revisados documen-
Sube inflación a 4.48%
AGENCIAS MÈXICO
Luego de tres quincenas a la baja, la inflación en México volvió a subir, con lo que llegó a 4.48% a tasa anual en la primera mitad de marzo, revelan los datos publicados por el Instituto Nacional de Estadística y Geografía (Inegi).
En la primera quincena del tercer mes del año, el Índice Nacional de Precios al Consumidor observó un incremento de 0.27% respecto el periodo inmediato anterior, su alza más elevada para dicho periodo desde 2022.
El incremento general de precios en la primera quincena de febrero se ubicó por arriba del consenso de los analistas que era de 4.44% anual, pero dentro del rango de sus expectativas que iban de un mínimo de 4.26% a un máximo de 4.57% previsto por las 34 instituciones financieras consultadas por CitiBanamex.
El aumento quincenal estuvo influenciado principalmente por el alza en el precio de servicios relacionados con el periodo vacacional de Semana Santa como el transporte aéreo con un alza quincenal de 35.98%; servicios turísticos en paquete, 10.05%; así como productos como el pollo con un aumento de 7.04% y el limón, 5.01%.
El Índice de Precios Subyacente, que incluye los bienes y servicios cuyos precios son menos volátiles, observó un crecimiento quincenal de 0.33% y anual 4.69%, mayor al 4.66% observado en la quincena previa. A su interior, los precios de las mercancías incrementaron 3.96% a tasa anual y los de servicios, 5.57%.
En el mismo periodo, el Índice de Precios no Subyacente avanzó 0.09% quincenal, con lo que su alza anual fue de 3.84% contra el aumento de 3.42% observado en el periodo inmediato anterior. Dentro del índice, los precios de los productos agropecuarios crecieron 4.69% a tasa anual, mientras que los de energéticos y tarifas autorizadas por el gobierno aumentó 3.12%.
Finalmente, el Índice de Precios de la Canasta de Consumo Mínimo, que evalúa los precios de 176 productos y servicios que la conforman, contenidos en la canasta alimentaria y no alimentaria del Consejo Nacional de Evaluación de la Política de Desarrollo Social (Coneval), tuvo una variación quincenal de 0.17% y un aumento anual de 4.03%.

tos del litigio que mantiene el gobierno federal en contra de las empresas del Grupo Salinas para que se paguen adeudos penales.
El pasado miércoles, en la mañanera presidencial, Antonio Martínez Dagnino, jefe del SAT, informar que empresas de Grupo Salinas adeudan más de 63 mil millones de pesos al Servicio de Administración Tributaria (SAT).
Ante esto, el presidente López Obrador anunció que todos los detalles de este caso serían difundidos en una página de internet, para que pudieran ser revisados por la población, por especialistas fiscales y por abogados.
“Lo que queremos es que se informe bien y que se presenten también todas las pruebas, que se haga aquí una síntesis, un resumen, pero que el día de hoy o mañana se suban a una página del gobierno todas las pruebas, todos los juicios, todo lo que hay sobre este asunto, para que los ciudadanos, incluso los especialistas en la materia fiscal, los contadores, los abogados, puedan, con toda la información, tener un criterio de lo que está sucediendo con este asunto, con esta polémica”, dijo en Palacio Nacional.
| elheraldodetuxpan.com.mx | Sábado 23 de Marzo de 2024 16. NACIONAL
México dará 11 mil pesos a migrantes
AGENCIAS MÈXICO
El gobierno de México dará 11 mil pesos a migrantes venezolanos para que regresen a su país, confirmó Alicia Bárcena, titular de la Secretaría de Relaciones Exteriores (SRE), como parte del convenio que ambos países. El apoyo durará 6 meses, a través de los cuales, los sudamericanos recibirán mil 800 pesos al mes.
Bárcena explicó que el convenio llamado “Vuelta a la Patria”, firmado con el presidente Nicolás Maduro de Venezuela, busca facilitar el regreso de venezolanos a su país. De acuerdo con la Plataforma Regional de Coordinación Interagencial para Refugiados y Migrantes de Venezuela, liderada en conjunto por ACNUR y OIM, en México se encuentran 113 mil migrantes venezolanos que buscan llegar a Estados Unidos.
De gira por OAxaca, la Canciller dijo: “Acabamos de firmar un convenio con Venezuela, con el presidente Nicolás Maduro, que se llama Vuelta a la Patria. Nosotros estamos mandando venezolanos de vuelta a su país… pero el presidente nos ha instruido que cada migrante que vamos retornando a Venezuela tenga un apoyo como el que se da aquí de Jóvenes Construyendo el Futuro, Sembrando Vida. Entonces ya tenemos un monto que les estamos dando a los migrantes que regresan a Venezuela”.
Apenas ayer, decenas de inmigrantes que tratan de entrar a Estados Unidos (EU) por El Paso, Texas, derribaron una reja de contención en la frontera con México y sobrepasaron a un puñado de elementos de la Guardia Nacional apostados en la línea divisoria entre ambas naciones.


Quieren desaparecer poderes en Campeche
AGENCIAS MÈXICO
La senadora Cecilia Sánchez, del Grupo Parlamentario del PRI, anunció que solicitará la desaparición de poderes en Campeche “por la falta de gobernabilidad que ha provocado la gobernadora Layda Sansores San Román”.
En conferencia de prensa, la senadora dijo que, en estos momentos, hay manifestaciones de policías “de los cuales ella se ha burlado, a pesar de que las policías mujeres estuvieron en muchos riesgos, sin equipo, dentro del CERESO, fueron violentadas y pasaron momentos muy desagradables porque no llevaban el equipo adecuado”.
Campeche, dijo, siempre estuvo en los primeros lugares de seguridad, “es un estado tranquilo, no hay manifestaciones, es la primera vez que el pueblo se manifiesta de esa manera, bajo la burla de la gobernadora”.
La senadora dijo que la petición de los policías que se han manifestado es la remoción
de Marcela Muñoz Martínez, secretaria de Protección y Seguridad Ciudadana, pero ha sido protegida por la gobernadora Layda Sansores.
“Solo bastaron menos de tres años del gobierno de Morena para que el pueblo se manifestara y para que el pueblo hablara y pidiera la destitución, queremos denunciar todas las anomalías que han estado cometiendo con el cuerpo de policía y sobre todo nuestra solidaridad con ellos y con las mujeres policías que fueron violentadas”, refirió.
Layda Sansores, aseguró, “quiere quitarse todos los golpes como lo hace el Presidente de la República, siempre echándole la culpa a los gobiernos anteriores o diciendo que es una manifestación provocada por los demás partidos. Los partidos de PRI, PAN, PRD no tuvieron nada que ver en esa manifestación y el Movimiento Ciudadano no tiene ese poder de convocatoria, así que por favor no estén inventando cosas”.
Layda Sansores, afirmó la senadora, “tiene que irse porque no ha sabido hacer las cosas, porque solo ha hecho una burla de nuestro Estado”.
Afores reportaron plusvalías
AGENCIAS MÈXICO
En febrero, las Administradoras de Fondos para el Retiro (afores) registraron plusvalías por 39 mil 383.9 millones de pesos de acuerdo con la Comisión Nacional del Sistema de Ahorro para el Retiro (Consar).
La cifra reportada el segundo mes de 2024 contrasta con las minusvalías que reportó el organismo en igual período del año pasado, cuando ascendieron a 121 mil 117.3 millones de pesos.
Además, el monto reportado en febrero fue mayor a las plusvalías registradas en el primer mes de 2024 cuando ascendieron a 21 mil 052.2 millones de pesos.
De acuerdo con el organismo regulador, las ganancias registradas en lo que va del año ascienden a 60 mil 436 millones de pesos, mismas que están relacionadas con la recuperación de los mercados de capitales, lo que ha contribuido a que se reevalúen las carteras de
los trabajadores.
El organismo precisó que, en los últimos 12 meses, las administradoras acumulan un saldo positivo por 505 mil 999.4 millones de pesos.
Las plusvalías y minusvalías son fluctuaciones en los precios de los activos que sólo se hacen efectivas como ganancias o pérdidas en los portafolios de los inversionistas cuando éstos modifican sus tenencias de los activos en cuestión.
Desde inicios de año, el presidente de la Asociación Mexicana de Administradoras de Fondos para el Retiro (Amafore), Guillermo Zamarripa, anticipó que 2024 será un año de plusvalías para los trabajadores afiliados.
Debido a las condiciones económicas y financieras es alta la probabilidad de que haya plusvalías al cierre de año”.
Sin embargo, aclaró que éstas no alcanzarán las registradas en 2023, cuando llegaron a 464 mil 068 millones de pesos.
Será un año de plusvalías pero moderadas debido a que continuará la alta volatilidad financiera, la inflación permanecerá estable y las tasas de interés bajarán lentamente”.

| elheraldodetuxpan.com.mx | Sábado 23 de Marzo de 2024 .17NACIONAL
Bacteria carnívora se extiende
Japón contabilizó 474 casos de síndrome de choque tóxico estreptocócico
AGENCIAS JAPÓN
El gobierno japonés intentó el viernes calmar los temores vinculados con un reciente brote de infecciones graves causadas por una bacteria. Entre principios de año y el 13 de marzo, Japón contabilizó 474 casos de síndrome de choque tóxico estreptocócico (STSS, por sus siglas en inglés), una forma de infección severa causada por la bacteria estreptococo del grupo A (EGA), según el instituto de enfermedades infecciosas de Japón.
En modo de comparación, en todo 2023 se registraron 941 casos. Corea del Norte informó el jueves a Japón de que no podía acoger en su territorio un partido de clasificación para el Mundial 2026 entre sus dos selecciones, que en principio estaba previsto para el próximo martes, según la Federación Japonesa de Futbol.
Japón trata de calmar a su población por bacteria carnívora
Pyongyang no especificó el motivo, pero se cree que la epidemia en Japón sería la causa, según la agen-

cia de noticias japonesa Kyodo. El portavoz del gobierno japonés, Yoshimasa Hayashi, se negó el viernes a comentar la decisión de Pyongyang, pero insistió en que Japón no es el único país afectado.
Desde el final de la pandemia de covid-19, “el número de pacientes con infecciones de las vías respiratorias ha aumentado en varios países, incluido Japón”, declaró Hayashi en su rueda de prensa habitual. También se han producido oleadas
EU presenta propuesta de presupuesto
AGENCIAS ESTADOS UNIDOS
Un grupo de legisladores de ambas cámaras del Congreso de Estados Unidos presentaron este jueves un acuerdo presupuestario que acaba con la ayuda a la Agencia de la ONU para los Refugiados Palestinos (UNRWA) y refuerza la frontera con México, con más agentes migratorios y más fondos para tecnología de vigilancia.
El paquete presupuestario de 1.2 billones de dólares está destinado a financiar las diferentes agencias del gobierno federal por los próximos seis meses, es decir, hasta el 30 de septiembre, que es cuando acaba el año fiscal 2024.
Los legisladores entran ahora en una carrera contra reloj para dar luz verde al proyecto antes de la medianoche del viernes, cuando se vence el plazo para aprobar un nuevo paquete presupuestario.
De no alcanzar los votos suficientes, la administración se verá obligada a cesar sus actividades, al quedarse sin fondos, algo que en Estados Unidos se conoce como “cierre de gobierno”.
El texto legislativo fue avalado tras intensas negociaciones entre líderes del Partido Republicano y el Demócrata de ambas Cámaras e incluye concesiones a la agenda conversadora como el aumento de presupuesto para “seguridad fronteriza” y el retiro de los fondos de Estados Unidos a la UNRWA hasta marzo de 2025.
A finales de enero, Washington pausó de manera “temporal” el financiamiento a la agencia de la ONU, después de que Israel denunciara que algunos de los empleados de UNRWA estuvieron supuestamente vinculados con el ataque de Hamas a Israel del 7 de octubre.
Estados Unidos es el principal donante de esta agencia de la ONU,

Rusia declara a movimiento LGBT como “terroristas”
AGENCIAS
Rusia añadió lo que llama el “movimiento LGBT” a una lista de organizaciones extremistas y terroristas, según una nota del servicio de inteligencia financiera consultada por medios estatales.
de infecciones por estreptococos del grupo A en 2022-2023 en Europa, Norteamérica y Australia.
Esta bacteria se transmite principalmente por contacto directo con secreciones corporales. El ministerio japonés de Salud ya hizo en enero un llamado general a la población para que continúe tomando precauciones, como lavarse las manos regularmente o llevar una mascarilla en lugares públicos concurridos.

que provee ayuda humanitaria a los habitantes de los territorios palestinos, incluyendo Gaza y el retiro de la financiación a la agencia fue calificado como “inhumano” por la secretaria general de Amnistía Internacional, Agnes Callamard.
La agencia abrió una pesquisa para indagar en estas denuncias y tras conocerse un informe preliminar, donde se concluyó que la agencia respeta el principio “de neutralidad”, Canadá y Suecia decidieron restaurar su apoyo financiero, que habían retirado siguiendo la decisión de Estados Unidos.
La medida estaba en consonancia con un fallo de la Corte Suprema de Rusia en noviembre pasado según el cual los activistas LGBT deberían ser designados como extremistas, una medida que los representantes de personas homosexuales y transgénero dijeron que temían que condujera a arrestos y procesamientos.
La lista la mantiene una agencia llamada Rosfinmonitoring, que tiene poderes para congelar las cuentas bancarias de las más de 14 mil personas y entidades designadas como extremistas y terroristas. Van desde Al Qaeda hasta el gigante tecnológico estadunidense Meta y asociados del fallecido líder de la oposición rusa Alexei Navalny.
La nueva lista se refiere al “movimiento social LGBT internacional y sus unidades estructurales”, informó la agencia estatal de noticias RIA.
El presidente Vladimir Putin, recién reelecto para un nuevo mandato de seis años, viene diciendo desde hace tiempo que defiende “la familia” y la religión frente a un Occidente “decadente” e incluso “satánico”, endurecido las restricciones durante la última década a las expresiones de orientación sexual e identidad de género.
Desde 2013, una ley en Rusia prohíbe “la propaganda” entre menores de las “relaciones sexuales no tradicionales”. Esta legislación se amplió considerablemente a fines de 2022, para prohibir cualquier forma de “propaganda” LGBT+ en los medios, internet, libros y películas. Y en julio de 2023, los diputados rusos votaron igualmente una ley que prohíbe a las personas transgénero las operaciones quirúrgicas y las terapias hormonales.
Desde el inicio de la campaña militar en Ucrania lanzada en febrero de 2022, las autoridades rusas han reprimido en paralelo, y de manera creciente, a las minorías sexuales. El miércoles, las autoridades anunciaron por ejemplo haber puesto en prisión preventiva a los gerentes de un bar de la región de los Urales, que ahora se exponen a una pena de hasta diez años de cárcel por “extremismo” LGBT.
Según la acusación, “durante la instrucción se halló que los acusados, personas con una orientación sexual no tradicional (...) apoyan igualmente las opiniones y las actividades de la asociación pública internacional LGTB, prohibida en nuestro país”.
Es el primer caso penal por este motivo, si bien varios ciudadanos rusos fueron condenados en las últimas semanas a multas por publicar fotos con banderas arcoíris o, en el caso de dos mujeres, por difundir en internet un video de ellas besándose.
| elheraldodetuxpan.com.mx | Sábado 23 de Marzo de 2024 18. INTERNACIONAL
RUSIA

| elheraldodetuxpan.com.mx | Sábado 23 de Marzo de 2024 .19 COMERCIAL
Primavera: Concepto, historia y por qué ocurre
La primavera en México o el equinoccio de primavera comenzó el 20 de marzo a las 23:25 horas. El tiempo que durará es de 92 días, 18 horas y 49 minutos, por lo que llegará a su fin el 21 de junio con la entrada del verano.
La primavera es una de las cuatro estaciones del año (junto con el invierno, verano y otoño). Inicia durante el equinoccio y culmina cuando llega el solsticio de verano. No obstante, su duración puede variar dependiendo de la región del mundo.
Incluso, hay países en los que no existe como tal la primavera. Prueba de ello es Camboya en el cual la temperatura durante todo el año oscila entre los 30 y los 35ºC.
¿Qué es la primavera?
La primavera (del latín prima, “primer” y vera, “verdor”) es una de las cuatro estaciones climáticas en que está dividido el año de las zonas templadas del planeta, junto con el verano, otoño e invierno.
Pero a diferencia de estas últimas, la primavera se caracteriza por un ascenso gradual de la temperatura, dispersión de las lluvias, días más largos y soleados, y floración y reverdecimiento de las plantas de hoja caducifolia (que cae).
El reverdecimiento de las plantas ha ocasionado que culturalmente se asocie la primavera a las ideas del renacimiento, la resurrección, la alegría y la juventud, contra la asociación del invierno con la muerte. Esto puede percibirse perfectamente en las obras artísticas y musicales que le rinden tributo a la estación, como el fragmento correspondiente de Las cuatro estaciones de Vivaldi.
La primavera inicia, astronómicamente, con el equinoccio de primavera (del 20 al 21 de marzo en el hemisferio norte y del 21 al 23 de septiembre en el sur) y culmina con el solsticio de verano (cerca del 21 de junio en el hemisferio norte y el 21 de diciembre en el hemisferio sur).
Historia de la primavera
Las estaciones han tenido siempre un correlato o una explicación cultural o mitológica en los pueblos humanos, y la primavera en ellas ha jugado siempre un rol celebratorio, festivo. En la mito -


logía griega, por ejemplo, las estaciones se explicaron mediante el célebre rapto de Perséfone por el dios del inframundo, Hades.
Perséfone, cuenta la tradición, era hija de Deméter, una diosa agrícola y de la tierra, y al ser llevada por la fuerza bajo tierra al mundo de los muertos, se entristeció tanto y fue tan infeliz, que a Hades no le quedó más remedio que llegar a un arreglo: ella pasaría seis meses con él bajo tierra (correspondientes al otoño e invierno) y luego seis meses de vuelta con su madre (primavera y verano). Así, la época primaveral era para los griegos la celebración del retorno de la hija con Deméter, quien de pura alegría hacía florecer las plantas. La celebración del equinoccio de pri-

mavera era así frecuente no sólo en la cultura de los antiguos griegos, sino también de muchos pueblos europeos de religión panteísta, que comúnmente son referidos como celtas.
Se trata de un conjunto de pueblos más o menos parecido, ágrafos y de religión animista, que cada solsticio de primavera se reunían para celebrar el retorno de la fertilidad y del calor al mundo. Los celtas tenían además un calendario propio desarrollado a partir de los equinoccios y solsticios, al cual se sospecha responderían las ruinas del Stonehenge en Inglaterra.
¿Cómo eran las estaciones en la época prehispánica?
Durante la época precolombina,

habían divisiones temporales similares a las de ahora. Existían periodos de 65 días conocidos como huico que significa nube, fiesta y/o temporada. Asimismo, había cuatro estaciones: huico tusi numa, que era el momento en el que brotaban los retoños de las plantas y flores (equivalente a la primavera); huico dzavui, época de lluvias (equivalente al verano); huico sanu huiyu, temporada en la que se recogía la cosecha y se sembraba de nuevo (equivalente al otoño) y la huico yuhua que era el equivalente al invierno. ¿Por qué ocurre?
Desde un punto de vista astronómico, las estaciones se deben al movimiento de inclinación del eje terrestre, que ocasiona un reparto desigual de la luz solar entre ambos hemisferios, invirtiéndose cada seis meses. No es cierto que se deba al movimiento de traslación a lo largo de su órbita elíptica.
De allí que las estaciones sean contrarias entre hemisferio Norte y Sur, haciendo que la primavera boreal (norte) sea el otoño austral (sur), en los tres meses previos al solsticio del Trópico de Cáncer (abril, mayo, junio); y por su parte, la primavera austral (sur) coincide con el otoño boreal (norte), los tres meses previos al solsticio del Trópico de Capricornio (octubre, noviembre, diciembre).
Características de la primavera, ¿cómo se vive en México?
Durante la primavera, la temperatura ambiental se eleva y el aire se humedece. Gracias a esto, el clima es ideal para que los árboles produzcan nuevo follaje y para que las flores se abran mostrando todo su esplendor. Asimismo, la mayoría de las especies inician sus ciclos reproductivos, por lo cual se genera un ambiente cálido e incluso considerado como romántico.
También es una temporada de sufrimiento para las personas con alergia al polen, pues debido a la predominación de las flores, el polen está por todos lados.
Eso sí, los festejos por la llegada del final del invierno son muy comunes. Por ello podemos disfrutar de eventos como desfiles en las escuelas, ferias, exposiciones, eventos culturales, macro exposiciones.

| elheraldodetuxpan.com.mx | Sábado 23 de Marzo de 2024 20. DE INTERÉS
¡DOS MUERTOS!
Camioneta de Tecate que transportaba barras de hielo invade carril contrario y provoca tragedia
REDACCIÒN
JALACINGO
Accidente frontal que dejó como saldo miles de pesos en daños materiales, varios lesionados y dos personas fallecidas, mientras que los conductores de dos de las unidades involucradas resultaron solo con golpes que no pusieron en riesgo su vida, mientras que las unidades quedaron varadas y destrozadas sobre la carretera federal obstruyendo la vialidad.
Al lugar acudieron elementos de seguridad pública municipal, y paramédicos del sistema de protección civil de Tlapacoyan, quienes procedieron a la toma de conocimiento y valoración de los conductores de las unidades, respectivamente, constatando de los daños, mientras que los conductores fueron atendidos y trasladados al hospital más cercano.
En este accidente fueron tres los vehículos involucrados, sien-
do un camión que transportaba barras de hielo, un vehículo compacto tipo Pointer que se llevó la peor parte y una camioneta donde el camión detuvo su loca carrera.
La unidad presunta responsable fue un camión marca Hino, modelo 300, color rojo con logotipos de la cerveza Tecate, misma que transportaba hielo y se dirigía a Martínez de la Torre para abastecer de hielo para el “Carnaval de los Cítricos 2024”, la cual era conducida aparentemente a exceso de velocidad, realizando rebases en la zona de curva donde invadió el carril contrario impactando de forma brutal a un automóvil de la marca Volkswagen, tipo Pointer, color blanco.
Tras el terrible encuentro de la camioneta y el auto, otras dos unidades que circulaban detrás y cuyos conductores no guardaron su distancia, también colisionaron contra estas.
Lamentablemente tanto el

trabajador de la cervecera que manejaba la camioneta y el conductor del Pointer murieron prensados entre los fierros.
De igual manera una camioneta se vio afectada en este accidente unidad que quedó destrozada de la parte delantera como resultado al fuerte choque frontal a causa de la irresponsabilidad y la falta de pericia del ahora occiso.
Elementos de Guardia Nacional Dirección Carreteras procedieron a realizar los peritajes pertinentes, además de solicitar el servicio de grúa quienes procedieron a realizar las maniobras para el traslado de los vehículos al corralón para lo conducente.
Mientras que el personal de la Policía Ministerial y Servicios Periciales realizaron las diligencias de rigor para poder llevar a cabo el levantamiento de los cadáveres y poder ser trasladados al semefo para ser reclamados por sus familiares.



| elheraldodetuxpan.com.mx | Sábado 23 de Marzo de 2024 .21 POLICÍACA

¡Encontronazo!
Diez personas lesionadas, y daños materiales, deja colisión entre tractocamión y un autobús
REDACCIÒN
PUEBLO VIEJO, VER.
Diez personas lesionadas, y elevados daños materiales, arrojó la colisión entre un tractocamión y un autobús de pasajeros.
Este accidente se registró alrededor de las 23:30 horas sobre la carretera TuxpanTampico, justo en el libramiento fray Andrés de Olmos, cerca de la gasolinera “Yugar”.
En este sitio el tráiler se incorporó sin la menor precaución, cerrándole el paso a un autobús de pasajeros color blanco dando lugar al violento impacto.
Lo anterior derivó la intensa movilización de cuerpos de auxilio, encabezados por elementos de Protección Civil de Pueblo Viejo, al mando de su titular René del Ángel Ánimas así como ambulancias y paramédicos de la Cruz Roja de Tampico.

Los ahora lesionados terminaron con diversos golpes contusos; por fortuna ninguno de gravedad.
La circulación se vio cerrada por varios minutos
Los heridos fueron trasladados a diversos hospitales del Puerto jaibo de Tampico, a bordo de las ambulancias.

Al lugar arribaron elementos de la Guardia Nacional División Caminos, para proceder al peritaje correspondiente.
Trascendió que el tráiler marca Kenworth color rojo con caja, fue el responsable, ya que terminó atravesado, tras cerrarle el paso al autobús de pasajeros color blanco.
Atracan a candidato
REDACCIÒN ZONGOLICA
Se dio a conocer que el candidato a diputado federal por el distrito XVIII de Zongolica abanderado por Movimiento Ciudadano Ignacio Ramírez fue víctima de un asalto mientras se desplazaba en su camioneta.
Su equipo de trabajo dio a conocer que Ignacio Ramírez Flores se desplazaba en la carretera Veracruz-Puebla cuando fue interceptado por asaltantes armados
Accidente vial
Dos automóviles chocan; uno de los conductores dio vuelta en U en un lugar prohibido
REDACCIÒN CARDEL
Fuerte accidente automovilístico se registró la mañana de este viernes en el libramiento de Cardel, donde uno de los conductores de los autos compactos, dio vuelta en U en un lugar prohibido.
Afortunadamente, este accidente vial no dejó personas lesionadas y los daños materiales fueron cuantiosos.
De acuerdo a datos recabados el responsable de esta colisión es quien manejaba un auto Chevrolet tipo Aveo, color arena, con placas de circulación TAN-976-B del Estado de Nuevo León.
Indebidamente realizó vuelta en U y de esta manera, impactó con su parte frontal a un vehículo de la marca FIAT,
tipo Panda, en color amarillo y con matrícula para circulares YAZ-982-B del Estado de Veracruz.
A pesar de lo fuerte que estuvo este accidente vial, ambos conductores resultaron ilesos y por lo tanto, no fue solicitada la presencia de los cuerpos de emergencias de Cardel.
El personal de Auxilio Vial de la caseta de cobro de La Antigua, se encargó de acordonar la zona y estuvieron pendientes a la llegada de un oficial de la Guardia Nacional División Caminos, para tomarán conocimiento del percance.
Los daños materiales cuantiosos y con el apoyo de grúas, ambas unidades fueron llevadas al encierro oficial de vehículos siniestrados.


quienes detuvieron el paso de su vehículo.
Los asaltantes luego de conseguir impedir el paso del candidato a legislador federal sacaron armas de fuego y lograron disparar contra su camioneta para exigir sus pertenencias.
Aunque lograron disparar a la unidad se indicó que no se tienen lesionados incluyendo al mismo candidato de Movimiento Ciudadano Ignacio Ramírez y el resto de sus colaboradores.
Pese a esto accedieron a entregar dinero en efectivo, equipo de telefonía y demás pertenencias de valor a fin de salvar la vida a fin de poder salvar la vida de todos los presentes.
Luego de recibir las pertenencias de Ignacio Ramírez se dieron a la fuga realizando más detonaciones en dirección al aspirante a diputado federal dejándolos en el sito.
Posteriormente Ignacio Ramírez se movió de la zona en dirección a la sierra de Zongolica. Hasta el momento ni el aspirante a diputado ni su partido Movimiento Ciudadano en Veracruz se han pronunciado sobre el asalto.
Se espera que Ignacio Ramírez se dirija ante las autoridades correspondientes para denunciar el asalto y la agresión con armas de fuego que sufrió en la carretera Veracruz – Puebla este viernes.
Sábado 23 de Marzo de 2024 22. POLICÍACA | elheraldodetuxpan.com.mx |
¡Lo apedrean !
Adulto en estado inconveniente saca su machete luego de insultar a un joven, para después ser agredido por este último sujeto
REDACCIÒN
POZA RICA
Policías municipales y estatales arribaron para verificar la situación, mencionándoles que un joven de aproximadamente 28 años iba caminando hacia su casa ubicada en las cercanías cuando el adulto mayor, que estaría en estado inconveniente, lo habría insultado y se hicieron de palabras. El señor sacó un machete de su vivienda y el otro implicado se defendió a pedradas logrando herirlo, por lo que desesperado rogaba que lo atendieran.
Ante ello paramédicos de Cruz Ámbar acudieron para valorar al señor que sufrió al menos tres cortadas en el brazo izquierdo, pero no ameritó ser llevado a un hospital y tampoco hubo detenidos debido a que cuando los oficiales llegaron ya estaban en sus casas.
Algunos lugareños señalaron a Francisco “N” como conflictivo y agresivo, explicando que en una ocasión con el machete le habría roto los cristales a un auto estacionado en dicha arteria, pero al llegar los uniformados ya estaba refugiado en su vivienda.

¡Sale del camino!
REDACCIÒN PEROTE
El percance ocurrió esta mañana, cuando la unidad era manejada con dirección a esta capital, procedente de la Ciudad de México, según lo informado.
Te puede interesar: Camioneta choca contra taxi y algunos bolardos en la zona centro de Xalapa

Muere abuelito
Hombre muerto queda tendido a un costado de la vía, luego de ser envestido por unidad de carga
REDACCIÒN NOGALES
El hombre de aproximadamente 70 años, quedó tendido a un costado de la vía rápida, luego de ser embestido por la unidad de carga, cuando intentaba cruzar hacía la carretera a Vicente Guerrero, que lleva al Hospital Regional de Río Blanco.
Pese a la respuesta inmediata de los grupos de auxilio, no lograron salvarlo, pues falleció de manera instantánea, procediendo los elementos policiacos al acordonamiento, de acuerdo al protocolo.
Personal de la Fiscalía Regional de Nogales, así como peritos forenses y Policías Ministeriales, dieron cuenta de lo ocurrido, ordenando el

Sin embargo, de repente el conductor perdió el control del volante y la unidad se fue de lado para terminar parcialmente en una cuneta.
Entre testigos también se dijo que al parecer el chofer tomó la curva a exceso de velocidad, lo que provocó que el autobús se desplazara sin con-
trol y se saliera de su carril.
El percance fue reportado a la línea de emergencias 911 y a la brevedad se movilizaron elementos de Seguridad Pública para apoyar con el
abanderamiento correspondiente.
Posteriormente, se presentaron efectivos de la Guardia Nacional División Carreteras para realizar las primeras
traslado del cuerpo al anfiteatro, en espera de su identificación y reclamación por parte de familiares.
Se dio a conocer que, el conductor huyó del lugar tras atropellarlo, por lo que serán sus familiares, quienes tendrán que afrontar los gastos, debido a que no hay a quien exigirle que responda por la muerte del septuagenario.
investigaciones y solicitar el apoyo de una grúa para regresar al autobús a la autopista. s oficiales también se movilizaron para prevenir a los demás automovilistas y con ello prevenir un accidente mayor, pues el autobús quedó en plena curva.
Según testigos, ese tramo de la autopista a Perote es considerado como peligroso, pues se han registrado choques y volcaduras, principalmente de unidades pesadas.
El tráfico vehicular quedó parcialmente obstruido en ese lugar a causa del percance y de las maniobras de emergencia realizadas por rescatistas.
| elheraldodetuxpan.com.mx | Sábado 23 de Marzo de 2024 .23POLICÍACA
el Heraldo de Coatzacoalcos
Sábado 23 de
PRIMERA SECCIÓN
PRIMERA SECCIÓN
Jueves 21 de Marzo de
Jueves 06 de Julio de

Marz0 de 2024 24. ESPECIAL | elheraldodetuxpan.com.mx | 14.
20.
2024
2023

Sábado 23 de Marz0 de 2024 .25 ESPECIAL | elheraldodetuxpan.com.mx | .15 PRIMERA SECCIÓN Jueves 21 de Marzo de 2024 .21 PRIMERA SECCIÓN Jueves 06 de Julio de 2023 el Heraldo de Coatzacoalcos
el Heraldo de Coatzacoalcos
el Heraldo de Coatzacoalcos
Alimentos ultraprocesados atrapan a mexicanos
Los ultraprocesados son diseñados mediante la ciencia de los alimentos y otras tecnologías y tienden a distorsionar los mecanismos del aparato digestivo y el cerebro.
EL UNIVERSAL CIUDAD DE MÉXICO.
Una mordida no basta: son exageradamente sabrosos o eso nos hacen creer. Tras la explosión de chocolate y crema batida o el adictivo crujir de una papa frita hay una larga lista de grasas, almidones, aglutinantes, azúcares, emulsificadores, saborizantes, solventes, aromatizantes, espesantes y estabilizadores mediante los que son procesados para recrear una deliciosa fantasía que inunda 80% de los estantes de los supermercados también en forma de galletas, cereales, jugos, tartas, frituras, helados y cientos de productos seductores.
Los llamados alimentos ultraprocesados son formulaciones industriales hechas a partir de sustancias derivadas o sintetizadas de diversas fuentes orgánicas. La mayoría de estos productos contienen pocos alimentos enteros o ninguno, y tienen un muy bajo valor nutricional, como unas papas fritas.
Mientras que un producto procesado es un alimento alterado por la adición de alguna sustancia que generalmente prolonga su dura-
ción, pero que conserva su identidad básica, como unas verduras congeladas.
Los ultraprocesados son diseñados mediante la ciencia de los alimentos y otras tecnologías y tienden a distorsionar los mecanismos del aparato digestivo y el cerebro. Las señales de saciedad y control del apetito quedan a su servicio. No es publicidad, el que no se pueda comer solo uno está en su creación.
Instituciones como la FAO han alertado por el aumento de su consumo en todo el mundo, principalmente en los sectores de menos ingresos, favoreciendo la obesidad, uno los de los problemas de salud pública más graves de México, donde es considerada una epidemia con cifras que alarman y no disminuyen: más de 70% de la población tiene sobrepeso u obesidad, somos el primer lugar mundial en obesidad infantil y hay más de 10 millones de personas con diabetes.
El documento de la OMS Alimentos y bebidas ultraprocesados en América Latina: tendencias, efecto sobre la obesidad e implicaciones para las políticas


DE LA MODA, ¿LO QUE ACOMODA?
públicas los describe: “Son característicamente grasosos, salados o azucarados, y bajos en fibra alimentaria, proteínas, diversos micronutrientes y otros compuestos bioactivos.
Su verdadera naturaleza suele disimularse mediante un sofisticado uso de aditivos. Si bien algunos de estos aditivos son inocuos, la seguridad de otros, solos o combinados con diversas sustancias alimentarias, se desconoce o está en entredicho”.
AMOR A LA PRIMERA MORDIDA Recientemente se aprobó en nuestro país una iniciativa para un nuevo tipo de etiquetado hexagonal frontal que busca alertar de forma más clara cuando los productos excedan los límites de grasas saturadas, sodio, azúcares o calorías.
La nutrióloga Paola Zarza, especialista en obesidad y comorbilidades, señala que la actual tabla de información nutrimental se conservará, pero sumando esta nueva alerta que pretende darle más claridad al consumidor sobre un producto que podría no ser tan benéfico para su salud. Se estima que sólo 13% de la población entiende el etiquetado actual, incluso con las adecuaciones que se hicieron hace cuatro años siguiendo las Guías Diarias de Alimentación, basadas en el sistema europeo.
Para Zarza, el problema es que tal como muestran estudios de la Profeco, a la gente en realidad no le interesa el contenido nutricional de un producto; se guía más por el precio y la conveniencia de comprarlo en un hábito similar a lo que sucede con el tabaco, pues aunque se anuncian los riesgos, el consumo continúa.
México es el cuarto país de Latinoamérica en aprobar este tipo de etiquetado, después de Chile,
Está el otro lado de la moneda: los mitos y modas que rodean a lo que se considera una buena alimentación. La nutrióloga dice que en la actualidad se ven mucho los llamados “detox”, que tienen la premisa de desintoxicar al cuerpo. “Son cuestionables porque nuestro hígado es el ‘detox’ natural. En realidad estas dietas extremas no desintoxican, sólo hacen perder agua y masa muscular”. Hay otras palabras en este glosario alimenticio que parecen haberse vuelto el enemigo público número uno, como el gluten. Zarza dice que se debe entender que el gluten es una proteína que se encuentra en ciertos tipos de cereales. Es la que permite que se esponje, por ejemplo, el pan. “Es verdad que hay gente alérgica a esto, como los celiacos que sí deberían restringirlo, pero el problema es que la gente lo evita por otras razones, como el temor a engordar y este producto no tiene ni menos calorías ni menos carbohidratos”.
La nutrióloga comenta que existen temporadas donde prevalece el nombre de alguna dieta como ahora sucede con la dieta keto o cetogénica, caracterizada por restringir todos los carbohidratos. “Es importante recordar que cuando retiramos todo un grupo de alimentos se pueden perder otras cosas, así que es necesario estudios de laboratorio para propiciar la pérdida de peso de la manera más sana”, señala y agrega que, por ejemplo, a un niño no se le pueden quitar todos los carbohidratos.
También hay otros tipos de alimentación, como la vegetariana y vegana, que se desaconsejan en la infancia, lactancia o en adultos mayores. La diferencia entre estos dos últimos tipos de alimentación es que en la primera hay consumo de alimentos de origen animal como leche y huevo, y generalmente no se presentan deficiencias de nutrientes; en cambio en el vegano hay poco aporte nutricional, y puede haber deficiencias de hierro, vitamina B12, vitamina D y calcio.
“Puede llegar fácilmente una anemia, se requiere suplementación para no comprometer la salud. Un error recurrentes es que se piensa que, por ejemplo, las espinacas están llenas de hierro y su consumo aporta lo necesario al organismo, pero la realidad es que el hierro en los vegetales no está tan disponible como en otros alimentos”. La especialista señala que el peso ideal, al final, tiene que ver con el equilibrio y los hábitos de vida.
“La obesidad es multifactorial, pero entre 50% y67% de las calorías provienen de productos procesados, pues ya no se comen alimentos naturales e incluso alimentos que eran elaborados en nuestro país por tradición, como las salsas”. Otro factor que mantiene el problema a flote es que somos el principal consumidor de refrescos. Si a esto le sumamos el sedentarismo, el coctel a favor del sobrepeso y la obesidad parece incontrolable.
Zarza concluye que también se trata de factores que están muy relacionados con el sistema educativo, por lo que se tendría que incidir en políticas públicas que abarquen diferentes áreas. Subraya que si no se ataca el origen de la susceptibilidad al consumo de ciertos alimentos, el simple etiquetado no resolverá un problema que ya ocasionó una rápida transición epidemiológica a enfermedades de adultos en niños, como la diabetes tipo 2.
Uruguay y Perú. En el estudio Evaluación de la Ley Chilena de Etiquetado y Restricción de Publicidad de los Alimentos se muestra que en el caso de las bebidas y jugos azucarados, las compras en ese país cayeron 25%, mientras que en los postres fue de 17%. Los de más impacto fueron los cereales para desayuno, con una baja de 36%. Por otra parte, Paola

Zarza señala que en Uruguay existen reportes de algunos efectos positivos en la población infantil, pero más allá de eso, lo que se ve


Sábado 23 de Marz0 de 2024 26. ESPECIAL | elheraldodetuxpan.com.mx | Jueves 11 de Marzo de 2021 www.heraldodecoatzacoalcos.com.mx 12. EL HERALDODE COATZACOALCOS Martes 14 de Julio 2020 heraldodecoatzacoalcos.com.mx 10. DE COATZACOALCOS Martes 11 de Febrero 2020 heraldodecoatzacoalcos.com.mx 10. DE COATZACOALCOS Jueves 28 de Noviembre 2019 heraldodecoatzacoalcos.com.mx 12. DE COATZACOALCOS
PRIMERA SECCIÓN Lunes 02 de Enero de 2023
28. PRIMERA SECCIÓN Jueves 06 de Julio de 2023
28.16. PRIMERA SECCIÓN Jueves 21 de Marzo de 2024









Sábado 23 de Marz0 de 2024 .27 ESPECIAL | elheraldodetuxpan.com.mx | .17 .29 .29 Jueves 11 de Marzo de 2021 www.heraldodecoatzacoalcos.com.mx .13 EL HERALDODE COATZACOALCOS Martes 14 de Julio 2020 heraldodecoatzacoalcos.com.mx .11 DE COATZACOALCOS Martes 11 de Febrero 2020 heraldodecoatzacoalcos.com.mx .11 DE COATZACOALCOS Jueves 28 de Noviembre 2019 heraldodecoatzacoalcos.com.mx .13 DE COATZACOALCOS PRIMERA SECCIÓN Lunes 02 de Enero de 2023 el Heraldo de Coatzacoalcos Martes 11 de Febrero 2020 heraldodecoatzacoalcos.com.mx .11 DE COATZACOALCOS Jueves 28 de Noviembre 2019 heraldodecoatzacoalcos.com.mx .13 DE COATZACOALCOS Martes 14 de Julio 2020 heraldodecoatzacoalcos.com.mx .11 DE COATZACOALCOS Martes 11 de Febrero 2020 .11 COATZACOALCOS Jueves 28 de Noviembre 2019 heraldodecoatzacoalcos.com.mx .13 DE COATZACOALCOS PRIMERA SECCIÓN Jueves 06 de Julio de 2023 el Heraldo de Coatzacoalcos PRIMERA SECCIÓN Jueves 21 de Marzo de 2024

‘SOY NACO, CURSI, CACHONDILLO... Y TOTALMENTE CHIVA’
El ‘youtuber’ y ‘standupero’ heredó de su abuela una receta para hacer un mole memorable, planea su día desde las 5 de la mañana, quiso ser futbolista y fantasea con frecuencia ser el Hombre Araña.
Sábado 23 de Marz0 de 2024 28. ESPECIAL | elheraldodetuxpan.com.mx | 18. 30.30.26. 26. Jueves 11 de Junio 2020 heraldodecoatzacoalcos.com.mx 26. DE COATZACOALCOS
SOSA
DANIEL
Martes 02 de Febrero de 2021 heraldodecoatzacoalcos.com.mx EL HERALDODE COATZACOALCOS PRIMERA SECCIÓN Sábado 07 de Agosto de 2021 EL HERALDODE COATZACOALCOS PRIMERA SECCIÓN Martes 28 de Marzo de 2023 el Heraldo de Coatzacoalcos PRIMERA SECCIÓN Jueves 06 de Julio de 2023 el Heraldo de Coatzacoalcos PRIMERA SECCIÓN Jueves 21 de Marzo de 2024
PRIMERA SECCIÓN
el Heraldo de Coatzacoalcos
el Heraldo de Coatzacoalcos
CANES TRAS EL RASTRO DE DESAPARECIDOS
Un grupo de 50 perros especializados son entrenados también para localizar explosivos, armas y drogas en el Estado de México.
El Estado de México cuenta con cuatro agrupamientos caninos. Unos son entrenados para apoyar en la búsqueda de personas desaparecidas, lo cual comprende desde desastres naturales, extravíos en áreas naturales y las que tienen reporte de no localizadas ante las autoridades.
Las otras tareas son para encontrar cadáveres, localización de explosivos, drogas y armas. Ellos forman parte de la Subdirección de Montada, Caninos y Gama en la Secretaría de Seguridad mexiquense, explica el titular del área Humberto Aguilar Valdés. Dijo que dentro de las responsabilidades de esta célula de la policía estatal está garantizar la seguridad de la ciudadanía y que son una corporación especializada que contribuye para ello con caballos y caninos que llegan a sitios inaccesibles para los efectivos.
Actualmente hay 50 perros entrenados y activos, además de 27 cachorros, que surgen de la cruza de los perros sementales de rotweiller, pastor alemán, pastor belga malinois y labrador, que cuando cumplen 10 años sustituyen a los que se tienen que jubilar. En entrevista para EL UNIVERSAL dijo que tanto perros como policías están certificados en España, Europa y Estados Unidos, de modo que hay entrenadores que determinan qué canes sirven para cada una de las activi-
PRIMERA SECCIÓN
PRIMERA SECCIÓN
Jueves 21 de Marzo de 2024
Martes 28 de Marzo de 2023
Jueves 06 de Julio de 2023

Sábado 23 de Marz0 de 2024 30. ESPECIAL | elheraldodetuxpan.com.mx | 20. 26.26. PRIMERA SECCIÓN Miércoles 27 de Octubre de 2021 10. EL HERALDODE COATZACOALCOS Lunes 03 de Mayo de 2021 www.heraldodecoatzacoalcos.com.mx 10. EL HERALDODE COATZACOALCOS Miércoles 26 de Agosto 2020 heraldodecoatzacoalcos.com.mx 10. DE COATZACOALCOS Sábado 04 de Enero 2020 heraldodecoatzacoalcos.com.mx 12. DE COATZACOALCOS
EL UNIVERSAL TOLUCA, MÉX.
PRIMERA
PRIMERA
PRIMERA SECCIÓN
dades y los van incorporando a las células porque no todos tienen las mismas cualidades. Hay algunos especializados en localizar drogas, otros explosivos, pero los más solicitados desde hace un año y medio a la fecha son para la búsqueda de personas y de cadáveres, dijo el también capitán del Ejército. Reconoció que, si bien “no puede presumir de los resultados de su corporación”, está convencido que son los mejores del país.
BINOMIOS QUE BUSCAN A LOS DESAPARECIDOS
Aguilar Valdés explicó que desde mediados de 2017 cuando asumió su cargo al frente de esta área en la Secretaría de Seguridad, identificó un especial interés por parte de la Fiscalía de Justicia, quien solicitó el apoyo de los binomios para contribuir en la búsqueda de personas.
Detalló que para contribuir con ello los canes reciben una capacitación distinta a los antibombas o antidrogas, por ejemplo, dijo, “es como se observa en las películas o la series policiacas, donde le dan a oler una prenda al perro y se ve que corre a buscar a la persona desaparecida: es igual”.
Para desarrollar esta actividad, destacó, desde cachorro el perro debe presentar determinadas características, por ejemplo, tener carácter pasivo, inteligente, y son más sagaces en comparación con los que buscan enervantes, por ejemplo.
Una de las aristas de este trabajo es la búsqueda de personas que se extravían en áreas inaccesibles, ya sea la sierra, el bosque, los volcanes. Para incursionar ahí se requieren perros fuertes con una buena constitución física, buen olfato y ágiles.
CASOS DE ÉXITO
“Hemos tenido resultados en la localización de personas, por ejemplo, en Tlalnepantla localizamos un cadáver recientemente, que es el objetivo. Se trató de un caso muy destacado porque logramos dar con el paradero de una persona”, resaltó.
En Nezahualcóyotl, dijo, tras el deslave de un basurero se quedaron atrapadas personas, algunos familiares no hallaban entre los escombros ni entre los cadáveres a sus seres queridos y fue cuando llegaron los binomios. Los perros localizaron a estas personas, algunos ya muertas, pero “creo que dimos algo de tranquilidad”.
CAPACITACIÓN PARA EL PERSONAL Y PERROS
Los entrenadores, quienes son los responsables de instruir a los canes acuden a cursos en el
el Heraldo de Coatzacoalcos
el Heraldo de Coatzacoalcos

LA PREPARACIÓN
Aguilar Valdés agregó que el tiempo para el adiestramiento del perro varía: inicia a los seis meses de edad del cachorro cuando comienzan a enseñarle obediencia, olfato, y al año ya comienzan con la localización de la actividad en que se van a desempeñar.
Todo esto lo hacen con “pseudos”, una clase de sustancia que elaboran empresas que iguala en 100% a la de las drogas; es decir, están libres de todo maltrato o daño, pues emplean en lugar de marihuana o cocaína, esa alternativa.
“Con eso logramos que no sean perros adictos ni que se enfermen. Para nosotros es muy importante no maltratarlos, así como las personas cuidan a sus mascotas, o los compañeros a sus parejas, para nosotros los perritos son nuestros compañeros de trabajo, no los vemos sólo como caninos, sino que el policía y el can son uno solo”, aseguró.

extranjero y están certificados en España, Francia y México, se trata de comandantes que después son replicadores de su conocimiento dentro de la propia corporación, mientras que el subdirector se mantiene de forma permanente realizando cursos de manejadores caninos para cada agrupamiento de los mencionados.
Es un rol similar al de un director de la escuela de canes y equinos, donde también hay más de 100 elementos policia-
cos. “Nos mantenemos capacitando a los perros y también a los policías, comenzamos con los canes que ya están en edad para que desempeñen actividades y se especialicen en localizar drogas, personas, cadáveres y explosivos”, precisó.
Cada uno de los cuatro agrupamientos cuenta con un entrenador, que distingue las diferentes características del cachorro y lo asigna una célula en específico.

EL CUIDADO Y ALIMENTACIÓN
El área recibe dos veces al día el alimento, son croquetas de la más alta calidad y tienen personal asignado al cuidado de los perritos, por ejemplo bañarlos, limpiar jaulas, dar mantenimiento en el pequeño lago del sitio donde viven, una especie de rancho ubicado en Zinacantepec. También podan el pasto, atienden las caballerizas y en el lugar cuentan con veterinarios que brindan atención constantemente a los animales.
El alimento lo proporciona el gobierno del Estado de México y para ello realizan el cálculo para abastecerlo tri-
mestralmente. Para sustituir a los perros que se jubilan o a los que mueren por edad, ya que ningún ha fallecido en acción, la corporación tiene dos alternativas: La primera, es incorporar a los cachorros que surgen de la cruza de los perros que ya forman parte de la Unidad Canina. Sin embargo, esto, comentó Aguilar Valdés, al paso del tiempo, es un problema porque la calidad de la sangre se debilita porque son cruzas de hermanos con hermanos y esto genera que sean propensos a enfermedades; la segunda alternativa es comprarlos, pero esto no ha sido necesario este año, dijo.
Sábado 23 de Marz0 de 2024 .31 ESPECIAL | elheraldodetuxpan.com.mx | .27.27 PRIMERA SECCIÓN Miércoles 27 de Octubre de 2021 .11 EL HERALDODE COATZACOALCOS Lunes 03 de Mayo de 2021 www.heraldodecoatzacoalcos.com.mx .11 EL HERALDODE COATZACOALCOS Miércoles 26 de Agosto 2020 heraldodecoatzacoalcos.com.mx .11 DE COATZACOALCOS Sábado 04 de Enero 2020 heraldodecoatzacoalcos.com.mx .13 DE COATZACOALCOS
Marzo
2023
SECCIÓN Martes 28 de
de
Jueves
de Julio de 2023
06
Jueves 21 de Marzo de 2024
SECCIÓN
El Heraldo de Tuxpan
www.elheraldodetuxpan.com.mx
Sábado 23 de Marz0 de 2024
Camioneta de Tecate que transportaba barras de hielo invade carril contrario y provoca tragedia.
@Heraldo_Tuxpan

PASE A LA 21
ACCIDENTE VIAL
Dos automóviles chocan en Córdoba; uno de los conductores dio vuelta en U en un lugar prohibido. PASE A LA 22.

¡ENCONTRONAZO!
Diez personas lesionadas, y daños materiales, deja colisión entre tractocamión y un autobús en Pueblo Viejo. PASE A LA 22

MUERE ABUELITO
Hombre muerto queda tendido a un costado de la vía, luego de ser envestido por unidad de carga en Orizaba. PASE A LA 23.

¡DOS MUERTOS!